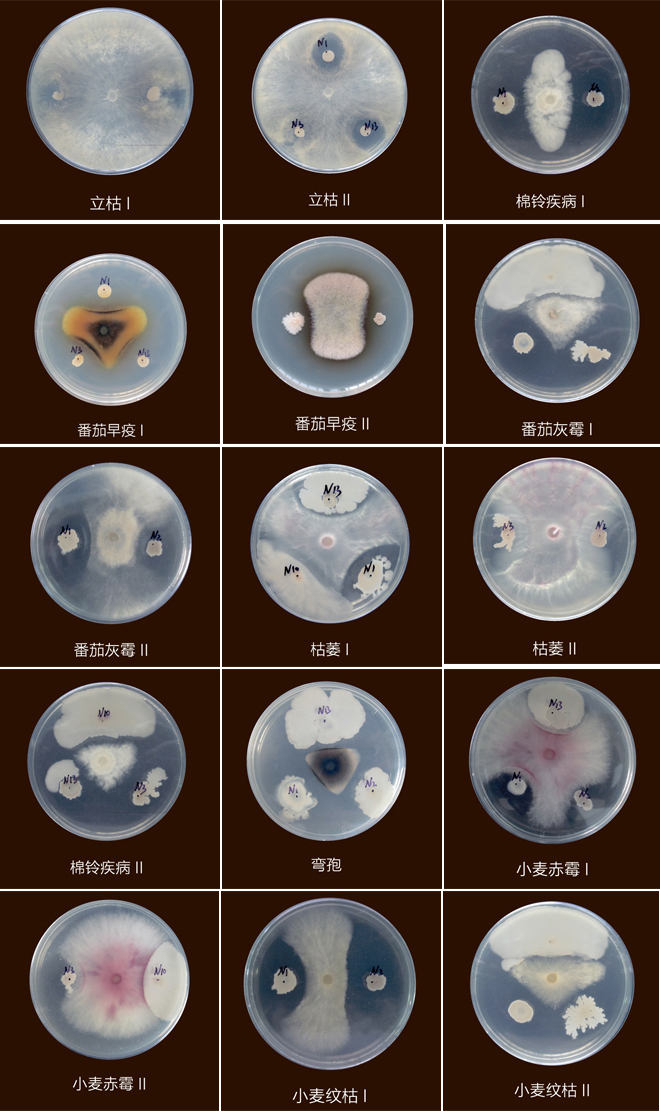
技術(shù)效果展示.jpg

日韩一区二区三区在线观看免费
|
欧美成人全部免费|
国产在线精品一区二区三区国…|
亚洲日本欧美系列|
成人在线免费小视频|
精品新一区二区三区四区|
粉嫩性色av一区二区三区蜜臀|
国产欧美亚洲一区二区欧美
|
免费观看黄a一级视频日本|
亚洲欧美日韩伦理|
精品人妻av中文字幕在线|
亚洲成人国产综合|
免费观看美女裸体网站久久|
亚洲天堂最新网址|
国产精品一区二区手机看片|
国产噜噜噜噜在线精品|
国产亚洲综合一区二区在线|
最新午夜综合福利视频|
国产免费人成在线视频app|
久久亚洲福利视频|
精品日本久久久久久人妻日本|
麻豆精品国产熟妇aⅴ一区|
欧美不卡的一区二区三区|
国产盗摄视频凸一区二区三区乱|
精品偷拍一区二区三区在|
免费黄色大片视频
|
国产婷婷久久综合五月欲色扒|
国产一区二区自拍视频|
国产一区二区三区在线|
麻豆久久精品影院|
青青青青草原国产免费|
国产日产欧美最新|
老司机成人精品视频在线|
中文字幕亚洲综合久久男男|
国产98av免费在线观看|
国产午夜激情视频|
日韩毛片高清黄色|
日本亚洲视频免费在线|
中文字幕在线观看免费看|
国产91对白刺激露脸在线观看|
免费在线观看av网站国产|
精品v亚洲v欧美ⅴ高清v 精品v亚洲v欧美v高清v 精品v欧美v亚洲v高清v 欧美高清v日韩v亚洲综合
|
91精品国产高清久久久久|
亚洲一区二区三区在线现观看|
人妻少妇猛烈插入中文字幕|
99精品国产成人观看免费不卡|
亚洲精品国产手机|
亚洲天堂最新网址|
久久人妻夜夜做天天爽|
午夜福利电影日韩|
精品一区二区三区久久|
国产亚洲欧美日韩综合综合二区
|
免费电影日本a中文字幕|
久久婷人人妻人人操人人爱|
亚洲国产成人aaa精品久久久|
午夜国产美女三级毛片
|
黄色视频免费观看一区久久|
亚洲精品视频在线观看久久|
久久最新免费视频6|
,天天爽夜夜爽夜夜爽精品视频
|
在线观看欧美日韩黄|
中文字幕xxx日韩在线|
日本在线激情免费播放不卡|
正在播放国产一区,二区|
日韩丰满少妇无码内射|
亚洲免费精品视频|
国产精品久久精品久久|
国产精品麻豆一区二区|
国产成人av综合在线观看|
亚洲产在线精品第一站不卡|
国产一级淫片a免费播放口|
亚洲一区二区三区高清免费|
精品国产大片久久久久久久久
|
亚洲一区二区三区四区a v|
精品v亚洲v欧美ⅴ高清v 精品v亚洲v欧美v高清v 精品v欧美v亚洲v高清v 欧美高清v日韩v亚洲综合
|
国产成人精品免费视频网站|
欧美亚洲日本国产一区三欧美|
欧美国产日韩在线激情观看|
在线观看国产成人av天堂野外|
国产91涩涩在线
|
亚洲精品一区二区三区观看|
欧美日本在线三级|
亚洲天堂久久精品成人|
激情综合欧美一区二区三区|
亚洲激情高清免费|
国产中文字幕一二三四|
在线观看国产视频|
欧美国产精品qv在线网站|
欧美一级黄片免费在线视频|
欧美蜜臀一区二区三区四区|
午夜成私人影院在线观看|
国产色偷丝袜麻豆亚洲|
色综合久久精品国产|
欧美黄色片一级片|
中文字幕在线日韩|
国产猛烈视频免费在线播放|
国产一级在线播放|
国产精品自拍视频亚洲|
日韩一区二区在线播放|
欧美一区二区三区一级特黄片
|
久久精品国产亚洲av久|
国产91在线播放九色0|
久久午夜激情视频|
亚洲高清日韩专区|
久久视频在线观看免费|
人人妻人人做人人爽91精品|
午夜美女福利免费视频|
亚洲精品国产伊人|
欧美黑人一级爽快片淫片视频|
69成人免费视频|
精品国产一区二区三区免费
|
av国语不卡在线观看|
最新国产三级久久|
伊人国产不卡久久中文字幕|
久久国产精品久久国产精品|
国产精品一区二区在线看片|
日本韩国国产在线播放网|
91精品在线观看视频|
中文字幕久久最新|
欧美丝袜变态亚洲另类|
欧美极品一区二区三区在线|
亚洲欧洲精品一区二区三区精品|
av网址深夜福利亚洲区|
国产一区二区三区欧美亚洲|
日本理论片手机在线观看影片|
亚洲国产日韩欧美中文高清视频|
亚洲精品色午夜久久久久|
人人人夜夜夜精品视频网站|
日本大波美女一区二区
|
国产精品自拍视频亚洲|
国产视频九九久久精品视频
|
国产日韩欧美成人|
日韩专区亚洲另类在线观看|
亚洲av黄片一区二区三区|
国产男女黄视频在线观看|
精品一区二区中文字幕绝色|
中文字幕日本人妻久久久兔费|
国产福利免费观看|
国产在线观看福利一区二区|
国产91涩涩在线|
欧美精品v欧洲在线观看|
欧美精品久久久久久综合网|
欧美天堂一区二区视频在线观看
|
欧美熟妇另类久久久精品|
午夜免费福利影院|
日韩欧美专区一区|
青青视频久久二区|
日本人妻中文字幕有码在线视频|
亚洲熟妇成人精品一区蜜臀
|
欧美这里只有精品|
国产精品一区91在线|
一区中文字幕在线观看免费|
99精品成人高清在线观看|
国产精品丝袜在线观看一区二区|
夜夜爽一区二区三区视频|
最近韩国日本免费播放大全|
一卡二卡三卡视频在线|
在线观看成人一区|
日韩精品久久在线观看|
国产精品自拍视频播放|
欧美日韩成人综合在线|
日韩中文字幕免费在线看|
精品一区二区三区久久|
亚洲精品一卡二卡免费在线观看|
在线国产日韩欧美视频|
国产精品3p一区二区三区|
偷拍,清纯,欧美,久久精品|
亚洲日本午夜福利在线|
欧美三级一级视频在线播放|
国产av麻豆色哟哟|
在线观看日韩欧美黄片|
日本高清一区二区三区高清视频|
欧美日韩一区视频在线观看|
www.蜜桃久久久|
欧美日韩一区二区中文成人|
亚洲国产精品中文字幕网站|
欧美一区二区三区日韩电影|
99久久夜色精品国产亚洲va|
欧美日韩另类亚洲精品一区|
亚洲国产人久久久成人精品网站|
欧美a级毛欧美1级a大片99
|
特黄特黄的欧美一级淫片|
午夜日韩一区二区|
国产三级在线观看播放不卡
|
又大又黄又粗高潮免费观看|
一区二区三区国产精品|
日韩视频精品一区|
欧美精品综合一区二区三区
|
日韩欧美国产视频一二三|
国产97精品在线观看|
狠狠爱亚洲狠狠热久久|
亚洲精品中文字幕9999|
国产制服av在线网|
欧美日韩一区二区高清视频大全|
99久久久国产精品免费99|
精品污污免费网站|
看片欧美日韩在线|
久久成人午夜免费电影|
欧美少妇一区视频在线观看|
人人干人人妻超碰人人爽|
成人免费观看一级黄色片|
亚洲午夜视频免费观看
|
日韩小视频在线播放|
国产五区在线观看|
亚洲 精品 国产 午夜|
少妇高潮久久久久|
婷婷夜夜躁天天躁人人躁
|
国产福利在线免费观看一区二区|
麻豆国产在线视频|
久久天天躁综合夜夜黑人鲁色|
欧美日韩国产在线偷|
国产中文亚洲精品|
国产三级香港三韩国三级|
欧美日韩亚洲国产一区|
欧美精品人妻一区二区三区蜜桃臀|
人妻不卡精品久久|
日韩一级毛一欧美一级乱|
国产麻豆日韩欧美|
在线视频亚洲精品|
日韩精品 一区二区 在线|
亚洲国产免费v片在线观看|
欧美亚洲日本韩国在线观看|
不卡视频在线观看国产|
久久久久九九精品影院|
国产一区二区在线观看我不卡|
国产直播一区二区三区|
中文字幕精品在线观看|
亚洲欧美黄色录像|
久久精品成人免费国产片桃视频|
免费一级欧美大片在线观看|
日本高清在线观看|
久久久久老司机精品视频|
国产在线精品福利91香蕉|
欧日韩不卡视频在线观看|
久久综合九九亚洲一区|
久久久久久熟妇热舞|
日韩丰满少妇无码内射|
欧美激情啪啪啪一区二区|
国产在线成人一区二区|
欧美一区二区三区大爽粗|
亚洲系列免费在线观看不卡|
国产av午夜中文字幕|
亚洲欧洲美洲综合在线|
国产精品一区二区在线看片|
夜色视频国产欧美|
久久久久国产精品人|
日本高清+成人网在线观看|
亚洲天堂日本一区|
露脸国产自产拍在线观看|
日本成人色一区二区三区|
日韩人妻中文字幕精品|
久久丝袜脚交足黄网站免费|
97色偷拍一区二区三区|
在线观看一区二区三区不卡|
免费一区二区三区不卡视频|
一区二区成人在线电影|
国产又黄又爽的刺激视频|
国产中国免费视频观看|
精品人妻一区二区二区四区四季|
蜜臀久久久亚洲精品国产|
狠狠躁夜夜躁人人躁婷婷视频|
国产中文字幕网站在线观看
|
国产精品一区二区三区影院|
午夜男女精品久久久久|
国产精品亚洲天堂网|
亚洲二三区免费在线观看|
国产精品一区二区免费|
精品视频一区二区三区四区五区|
久久中文字幕免费久久中文|
日韩欧美精品一区二区蜜臀|
在线观看国产一区二三区|
国产精品 中文字幕 欧美精品|
国产亚洲精品一区二区电影|
中文字幕永久在线第一页|
亚洲国产精品三级在线观看|
香蕉视频亚洲一级|
午夜视频在线观看国产片不卡|
午夜精品蜜桃久久|
亚洲精品成人午夜影院在线观看|
99久久精品一区二区|
天堂俺去俺来也www久久婷婷|
亚洲人在线观看视频不卡|
久久免费手机视频|
国产亚洲精品一区二区电影|
欧美独立一区二区三区视频|
视频一区二区欧美精品|
日韩一区二区三区在线观看免费
|
日本高清在线观看|
狠狠人妻久久久久久综合蜜桃久久|
欧美成人家庭影院|
国产成人成网站在线播放青青|
av在线免费最新观看|
亚洲不卡一不卡二不卡三|
欧美一区二区在线观看免费|
久久久久亚洲精品免费看|
欧美日韩午夜在线看|
国产尤物视频在线观看.|
国产网红主播在线诱惑av|
亚洲电影一区二区三区在线观看|
亚洲精品www视频在线观看|
成人乱码一区二区三区四区|
亚洲欧美日韩另类久久久精品|
国产不卡av中文字幕|
欧美+日韩+中文字幕+国产|
麻豆福利精品视频
|
欧美性与交视频在线观看|
午夜一级黄片在线|
精品一区二区久久久久黄大片
|
国产成人福利免费视频|
国产女明星专区视频在线播放|
久久亚洲精品成人av大尺度|
国产精品丝袜在线观看一区二区|
国产精品久久久久三一级|
亚洲另类伦春色综合小|
一区二区中文字幕最近第九页|
免费播放一区二区三区成人|
国产成人久久精品一区二区三区|
成av人一区二区三区久久|
日本人成视频免费一区二区|
日本一区二中文欧美视频|
久久一区二区av影院|
日本视频在线观看永久免费|
国产激情精品一区二区三区|
亚洲欧美日韩高清中文在线|
亚洲国产精品官网|
午夜精品久久久999麻豆|
国产亚洲精品久久久久久
|
www.日本乱码一区二区三区|
国产十八禁美女视频网站免费|
日本精品一区二区三区蜜桃|
日韩精品一区电影|
久久er99视频精品|
嫩草视频一区二区三区入口|
日韩欧美国产视频一二三|
国产不卡在线高清视频免费v
|
日韩一区二区三区在线观看免费
|
国产激情精品一区二区三区|
精品国产一区二区三区在线|
日韩精品视频久久|
午夜福利在线网址|
免费观看久久av 久久av免费播放
国产永久免费高清在线观看视频
2022国产精品永久在线
|
性高湖久久久久久久久AAAAA|
欧美午夜福利片在线|
麻豆精品国产三级在线观看|
欧美成人看片久久精品久久|
青青草原国产免费av|
中国做爰国产精品视频|
青青久久精品国产免费看夜夜嗨
|
天天爽夜夜太爽视频精品|
国产尤物视频在线观看.|
制服丝袜av一区二区三区|
av天堂资源在线亚洲精品|
精品丰满少妇A丫久久久久|
中文字幕欧美成人免费|
亚洲午夜视频免费观看|
黄片一区二区三区久久|
午夜偷拍福利一区|
久久精品私人影院免费看|
伊人久久五月天综合网|
国产人妻成人一区二区三区网站|
一区二区乱搞视频在线观看|
www.亚洲精品视频在线观看|
一区二区三区免费不卡视频|
最新国产三级久久|
一卡二卡日韩人妻|
9久国产精品黑人全免费视频|
国产精品久久久亚洲av|
国产av成人专区一区|
午夜在线免费观看视频|
国产欧美亚洲一区二区欧美|
亚洲欧美日韩另类久久久精品|
少妇久久久中出中文字幕|
欧美一区二区在线|
最新网址在线观看一区二区三区|
国产精品久久永久免费|
男女啊啊啊免费视频网站|
欧美日韩一本二本在线播放
|
亚洲一区男女那个的视频网站|
日本一区二中文欧美视频
|
亚洲精品视频在线观看久久|
久久一区二区av影院|
精品中文日韩字幕|
午夜大尺度福利视频在线观看|
国产日产美产精品精品av|
日本无遮挡在线播放视频网站|
国产成片免费视频app|
日本精品一区二区三区蜜桃|
精品一久久香蕉国产欧美综合|
中文字幕性av在线|
久久国产免费一区|
精品999久久久一品毛片|
国产一区二区三区av网站|
91精品婷婷色国产综合|
国产成av人在线免费观看|
激情久久av一区av二区av|
日韩欧美午夜福利一区二区|
日本一级二级三级久久|
久热国产精品视频|
性欧美长视频免费视频|
国产高中生视频在线观看|
欧美蜜臀一区二区三区四区|
久久精品视频影院|
国产香蕉av网站 国产香蕉av在线|
国产主播一区二区三区四区|
国产av网站欧洲亚洲美洲|
亚洲一区二区三区高清免费|
欧美一区二区另类|
美女诱惑av在线观看|
欧洲精品在在线观看|
欧美精品久久一区二区三区|
成人在线观看网站|
国产精品久久综合激情|
欧美一区二区三区久久久|
国产好片日本一区二区三区四区|
怡红院免费的全部视频国产a|
日韩精品一卡二卡在线|
久久久久久久久av免费观看|
伊人激情精品av一区二区|
欧美日韩免费在线视频|
中文字幕第一页在线播放|
日本丝袜中文字幕在线观看视频|
国产ts在线播放|
日本a级综合久久a|
国产福利在线观看一二三|
国产午夜三区视频在线|
一本一道久久a久久综合精品|
亚洲第一影院一区二区三区|
青青草原1769久久免费播放
|
久久香蕉国产国精品一区|
婷婷人妻在线播放|
精品视频一区二区三区四区涩爱|
最新国产三级久久|
国产亚洲中文在线观看网站|
最新免费精品福利视频网|
国产精品视频久久|
色婷婷综合激情五月免费观看|
国产男女做受高潮毛片一级|
好吊妞国产欧美日韩在线观看|
一区二区三区四区中文在线视频|
亚洲麻豆色欧美国产|
国产精品日本一区二区在线播放|
久久人人爽人人澡|
国产精品亚洲天堂国产精品|
在线视频观看日本韩国亚洲一区二区三区
|
亚洲国产麻豆成人在线播放
|
精品午夜国产在线观看不卡|
欧美成人精品不卡视频在线观看
|
亚洲av在线精品网裸体艺术|
亚洲精品视频在线观看久久|
久久亚洲精品成人av大尺度|
在线视频免费观看资源中文字幕|
国产日韩欧美亚洲专区|
日韩黄在线观看免费视频|
午夜成私人影院在线观看|
久久综合伊人77777|
亚洲综合图片人成综合网|
日韩亚洲欧美中文在线观看|
人妻中文字幕在线一区二区|
国产精品免费久久久久影院
|
中文字幕日韩激情欧美一区|
成年人免费视频网站大全|
亚洲国产精品三级在线观看|
亚洲一区二区三区另类小说|
欧美精品一区99视频官网一区|
中文字幕日韩av电影网|
久久综合九九亚洲一区|
国产精品精品国产一区二区|
国产精品久久午夜福利|
国产成人久久精品一区二区三区|
天天久久综合网站|
激情久久五月激情婷婷|
色综合一区二区三区在线视频|
国产精品十八藏久久久|
欧美极品一区二区三区在线|
精品在线电影中文字幕|
欧美综合社区国产|
国产成人精品一区二区秒播|
91久久久久久香蕉国产|
亚洲精品一区二区三区波多野|
手机看片高清国产日韩不卡|
国产精品久久久久三一级|
国产亚洲精品一品区99热|
欧美字幕日韩欧美一区二区|
久久免费精品性猛交蜜桃|
国产精品婷婷久青青原|
伊人精品在线观看|
精品一区两区视频在线观看|
成人看片亚欧大片在线观看|
国产日韩欧美亚洲专区|
亚洲免费www在线观看|
国产免费一区二区三区视频天天爽|
国产精品久久久久岛国欧美
|
欧美国产日韩在线激情观看|
色屋精品久久免费毛片|
亚洲乱码一区二区av高潮|
少妇高潮久久久久|
天堂俺去俺来也www久久婷婷|
精品视频一区二区三三区四区|
久久婷人人妻人人操人人爱|
青草香蕉精品视频在线观看
|
亚洲乱色视频久久网|
国产三级精品三级在专区中文
|
国产成人精品在线|
免费人妻久久久久|
91成人精品欧美|
久久午夜激情小视频|
欧美性黑人猛交xxxx免费看|
亚洲精品久久久久午夜电影网
|
亚洲欧美日韩成人在线观看|
久久久成人精品一区二区三区|
成人在线观看网站|
国产二区三区中文字幕|
欧美午夜在线成人|
日本一区二区中文字幕播放|
不卡无吗在线视频快速播放|
日本一本福利不卡中文字幕|
久久夜色撩人精品国|
欧美激情亚洲另类国产片|
国产成人精品专区|
日本无遮挡在线播放视频网站|
日韩中文在线一区二区三区|
黄色黄片大爽www 久久久|
欧洲特一级黄色视频|
成人精品一区二区三区,|
成人免费公开视频|
国产极品大乳在线观看|
91精品国产91久久综合|
国产成人在线午夜av|
国产欧美日韩中文久久|
一区二区三区精品免费观看|
日本高清免费的不卡视频|
亚洲黄av网站在线观看|
精品人妻一区二区二区四区四季|
亚洲成人一区二区三区免费|
国产a三级三级三级|
国产中文字幕五月天|
91深夜福利免费观看网站|
免费观看欧美一区二区三区|
精品人妻高清一区二区三区|
中文字幕成人午夜福利免费|
青青草原国产免费av
|
一个人在线日本免费观看视频
|
国语高清精品一区二区三区|
精品第一国产综合亚洲午夜|
欧美三级午夜理伦三级富婆|
五月天精品视频在线观看|
亚洲午夜免费精品|
日韩欧美精品一区二区蜜臀|
日韩欧美在线电影|
欧美日韩亚洲三区|
国产成人爽片在线观看|
亚洲午夜视频免费观看|
男人午夜的天堂视频在线观看
|
在线国产中文字幕av|
亚洲成人一区二区三区免费|
日韩精品免费在线观看|
国产欧美在线观看一区二区|
四虎影院精品在线观看|
91啦国产成人在线网站|
日本欧美一区二区三区不卡|
国产偷自视频区视频一区二区|
中文字幕欧美亚洲精品网站|
中文字幕成人精品久久不卡|
日本美女视频一区二区三区四区|
日本成人色一区二区三区|
日韩一区二区三区人妻在线
|
国产又粗又长免费观看视频|
91亚洲国产成人久久精品蜜臀|
国产日韩精品二区|
欧美va在线观看 午夜理论三级在线观看|
国产精品久久精品福利网站|
欧美福利在线精品国产|
日本黄色高清中文字幕在线播放|
日韩在线播放网址|
久久久久亚洲av成人人|
美女黄a视频永久免费观看|
中文字幕国产三级在线|
亚洲国产av综合一区二区|
日本成人影在线观看国产精品|
综合久久99久久99播放|
日本一区二区中文字幕播放|
精品一区二区三区小黄片|
视频一区二区三区国产网红|
日本一二三区不卡视频在线观看|
亚洲va在线va天堂va不卡
|
人妻 蜜桃 精品|
国产精品欧美精品中文字幕|
国产理论片久久午夜精品|
绯色av入口一区二区三区|
99久久国产日韩一区二区|
色国产在线视频一区|
亚洲精品国产伊人|
奇米久久久久久亚洲综合91|
欧洲成人全免费视频网站|
精品欧美在线观看|
日韩亚洲一区二区三区|
日本人体一区二区|
丁香婷婷综合亚洲激情
|
国产人妻熟女一区二区三区|
欧美日韩一本二本在线播放|
国产成人天天爽高清视频|
一区二区三区在线 不卡|
亚洲 国产 精品 激情|
午夜美女福利免费视频|
亚洲精品专区一区二区欧美|
乱子伦一级在线现看|
高潮又黄又爽又无遮挡久久久|
成人免费黄色网址|
欧美国产亚洲二区|
极品少妇内射在线视频精品|
91在线视频日本老司机|
国产免费看一级av|
99激情视频盗拍这里免费|
国产亚洲欧美日韩综合综合二区|
在线国产中文字幕av|
五月天丁香婷婷一区二区伊人|
国产亚洲综合一区二区在线|
国产精品多p对白交换绿帽|
97神马在线精品视频播放|
国产精品亚洲第一区焦香|
亚洲大尺码专区影院|
欧美少妇一区视频在线观看|
日本女优免费一区|
在线一区二区三区在线一区|
久久久免费视频观看黑人|
黄色国产精品一区二区三区|
日本黄色一级片免费看|
日本成人影在线观看国产精品|
国产一级在线观看视频|
国产亚洲精品播放|
欧美日韩国产成人综合在线|
亚洲精品视频在线免费观看不卡|
国产免费一区二区三区www|
欧美国产成人免费观看永久视频|
亚洲成人区一区二区三区|
精品丰满少妇A丫久久久久|
久久美剧免费在线观看|
大香蕉国产高清av|
精品国产91久久久久久一区黄无|
狠狠做六月爱婷婷婷综合av
|
国产精品高颜值在线观看|
欧美国产综合成人在线电影|
久草视频国产在线观看00|
人人干人人妻超碰人人爽|
一区二区激情在线观看|
91九色精品国产免费|
精品人妻一区二区三区香蕉|
日本亚洲免费在线视频观看
|
久这里有精品视频在线播放|
国产第一页在线观看|
亚洲午夜精品在线电影|
欧美日韩精品久久久久|
国产欧美一区二区视频在线观看|
久久国产国内精品对话对白|
韩国av永久免费 韩国成人禁片在线观看
|
亚洲午夜短片免费|
欧美日韩国产三级黄片|
蜜臀av国内精品久久久夜夜嗨
|
国产av婷婷爽av综合|
国产亚洲欧美精品综合久久|
日韩一区二区电影|
日本免费一卡二卡在线观看|
97av麻豆蜜桃一区二区
|
国产精品亚洲第一区焦香|
日韩欧美国产综合|
久久精品国产无限资源|
久久国产欧美一区二区三区
|
毛片不卡一区二区三区|
中文字幕欧美亚洲精品网站|
性高湖久久久久久久久AAAAA|
激情国产精品视频|
色婷婷在线高清免费观看|
国产乱码在线观看一区二区|
日韩av一本二本在线观看|
欧美日韩视频一区在线观看|
亚洲欧美日本韩国|
日本五十路一区二区三区在线观看
|
暖暖高清视频日本中文www|
亚洲天堂精品影院一区二区三区|
亚洲午夜视频免费观看|
亚洲欧美一区二区三区网|
欧美视频一区二区三区在线|
欧美三级日本在线观看成人|
精品国产青青在线观看爽香蕉|
国产av午夜中文字幕|
久久人人超97人妻香蕉免费|
九九国产在线视频|
午夜电影精品一区二区三区|
久久99欧美午夜精品久久久|
在线观看日韩视频免费观看|
麻豆精品视频在线观看91|
在线观看日韩视频免费观看|
欧美+日韩+中文字幕+国产|
久久久久久一区二区三5区|
国产日韩欧美亚洲专区|
欧美成人午夜视频在线观看|
国产日韩精品二区|
亚洲国产日韩欧美中文高清视频|
欧洲精品亚洲一区|
久久久久久人妻最舒服|
亚洲第一大福利网站在线观看
|
欧美在线日韩专区|
精品久久香蕉国产线看观看亚洲|
91超碰97精品在线观看|
亚洲精品久久久久久久蜜桃臀|
亚洲欧洲日产国产av|
欧洲精品在在线观看|
国产av婷婷爽av综合|
欧美日韩国产大片三区|
黄色影院一区二区三区久久久|
久久国产精品丝袜制服|
欧美视频手机在线观看|
国产精品国产三级在线专区|
中文字幕有码在线视频欧美|
被窝午夜理伦影片|
一卡二卡国产三卡四卡乱码日韩|
亚洲精品视频在线免费观看不卡
|
国产成人久久精品一区二区三区|
性做久久久久久蜜桃花|
日韩精品久久久视频|
久久精品网上视频免费观看|
国产欧美精品一区久久久
|
国产黄色大片在线观看|
日本韩国欧美一级片网站|
最新亚洲欧美日韩|
青青热久免费精品视频在线观看|
日本精品一区二区三区在线观看
|
在线 中文 字幕 日韩|
蜜臀一区二区三区不卡少妇|
精品动漫在线观看视频一区|
精品国产91久久久久久一区黄无|
国产日韩欧美视频高清在线观看|
成人黄色视频网站在线|
午夜社区在线观看|
欧美日韩激情一区第二页|
欧美一区二区三区激情电影在线|
欧美成人午夜视频在线观看|
久久久,av色综合|
亚洲国产精品自在在线观看|
欧美一级片视频中文字幕|
亚洲一区二区三精品在线观看|
亚洲一区男女那个的视频网站|
日韩人妻精品一区二区在线|
国产91av成人在线观看|
久久精品视频在线播放|
欧美成人午夜福利在线视频|
99在线精品国自产拍中文字幕|
国产成人久久久精品一区二区|
99r视频国产在线观看免费|
视频一区日韩经典中文字幕|
麻豆久久99精品福利久久久
|
国产欧洲精品亚洲午夜拍精品|
少妇久久久中出中文字幕|
国产中文字幕第5页|
精品欧美激情精品一区蜜桃|
五月天婷婷精品免费视频|
日韩一区二三区无|
成人一区二区三区免费视频|
免费观看国产高清黄片|
久久人做人爽一区二区三区介绍|
国产精品正在播放|
日本一区二区成年人网站|
国产福利视频在线观看|
久久av日韩午夜福利片|
国产成人在线小视频|
一区二区丰满少妇按摩高潮|
亚洲国产日韩在线人高清|
久久人妻中文系列|
日本黄色一级片免费看|
国产精品美女免费视频观看|
亚洲精品精华液一区|
真实国产乱子伦一区二区|
免费人妻久久久久|
日本一区二区在线视频免费观看|
亚洲精品久久久久中文|
成人在线一区二区|
亚洲午夜视频免费观看|
亚洲欧美日韩中文字幕制服丝袜|
日韩小视频在线播放|
亚洲欧美日韩中文视频专区|
综合久久综合久久|
杨幂国产福利在线观看|
亚洲精品视频在线免费观看不卡|
亚洲欧美日韩伦理|
999在线视频精品免费播放观看|
亚洲香蕉av一区二区三区|
黄色一级片高清国产精品|
欧美日韩色黄大片在线视频|
黄色一级片一区二区|
日本韩国一区二区网站在线观看|
亚洲免费成人日韩|
最新欧美日韩一区二区三区
|
亚洲天堂精品影院一区二区三区|
欧美国产亚洲二区|
亚洲欧美中文国产|
日本深夜福利视频在线播放|
美女被男的操到爽免费网站|
国产精品视频卡一卡二卡三卡四|
欧美一区二区三区午夜尖叫|
欧美精品亚洲第一页|
美日韩一级片欧美一级片
|
美女的胸18禁久久久久久久|
日本三级日产三级国产三级|
国产一区二区三区导航|
精品视频久久久久久久久|
少妇一区二区三区久久|
日韩裸体大尺度av一区|
国产一级淫片a免费播放口|
人妻少妇av中文字幕乱码|
激情欧美日韩一区二区|
国产精品高潮呻吟久久av号码|
亚洲色图美腿丝袜国产av|
在线看的网站中文字幕av|
欧美一级专区免费大片|
国产高清亚洲精品26u|
欧美日韩国产性行为|
亚洲一区二区三区欧美精品|
国产男女黄视频在线观看|
国产拍拍视频一二三四区|
日韩欧美在线观看高清视频|
国产婷婷久久综合五月欲色扒|
不卡精品一区二区三区在线观看|
久久综合国产精品一区二区
|
国产成人精品日本亚洲网站|
久久理论片午夜琪琪电影网
|
99r视频国产在线观看免费|
日韩三级免费毛片|
精品免费久久久久国产一区小说|
97神马在线精品视频播放|
欧美日韩网友自拍六区十区|
国产蜜臀av一区二区在线观看|
国产精品欧美精品中文字幕|
日韩欧美亚洲综合久久影院|
国产亚洲精品久久视|
亚洲精品国产伊人|
国产精品久久久国产盗摄蜜臀|
91精品国产高清自在线|
国产精品久久久久久久99影视
|
精品国产乱码一区二区三区99|
国产拍拍拍拍拍拍拍拍拍拍拍拍拍
|
成人免费一区二区三区|
日本二道本一区视频在线观看|
色欲天天天综合网|
最近最新中文字幕在线视频观看|
亚洲影视av在线一区二区三区播放
|
国产成人精品一区二区秒播|
麻豆果冻传媒精品二三区|
午夜在线免费观看视频|
在线观看美女成人av|
日本经典三级在线观看中文字幕|
亚洲动漫精品一区二区三区
|
国产精品久久午夜福利|
中文字幕在线观看视频第二页
|
亚洲综合国产一二三四五区|
一个人在线日本免费观看视频
|
激情日韩丝袜亚洲精品欧美|
成年人免费在线观看国产精品|
在线观看日韩成人日本视频|
国产精品精品国产一区二区|
2021日韩亚洲第一页|
日韩国产麻豆精品搜索在线观看|
麻豆国产在线视频|
日本一区二区三区免费播放|
国产午夜免费成人av|
日本高清一区二区三区在线观看|
97国际精品在线视频播放|
国产视频久久综合|
91精品国产91久久综合|
久久老熟女一区二区三区福利|
一区二区三区四区五区午夜福利|
亚洲精品一区二区三区综合|
久久国产精品久久|
字幕日韩视频一区二区|
亚洲欧美日韩另类久久久精品|
中文字幕在线乱码不卡二区区
|
男女啊啊啊免费视频网站|
亚洲精品精华液一区|
欧美三级在线视频|
免费在线观看一区二区不卡|
国产日本女不卡一区|
久久精品久久精品久久|
精品痴女中文字幕av网站|
日本激情视频免费观看网站
|
亚洲av片大全在线观看|
日韩影视成人中文字幕在线播放
|
五月天精品视频在线观看|
超碰资源人人澡麻豆精品|
自拍偷自拍亚洲精品偷一|
在线免费观看国产精品黄片|
亚洲韩国日本欧美一区二区三区|
又黄又湿又色的免费视频|
国产高潮呻吟网站在线观看|
亚洲精品经典自拍|
欧美激情一级精品国产|
久久久免费视频观看黑人|
日本 成人 精品 在线|
午夜精品电影推荐|
一本一道久久a久久综合精品|
精品国产一区二区三区在线看|
欧美成人午夜福利手机在线观看|
亚洲一区二区三区高清|
精品一区二区三区小黄片|
欧美精品黑人成人另类视频|
日本午夜视频@一级|
级a一级a爰片免费久久久|
精品动漫在线观看视频一区|
午夜久久久久久久影院免费观看|
日韩一级欧美一级国产|
日本美女一区二区电影|
亚洲免费成人日韩|
中文字幕在线播放午夜|
亚洲欧美日韩高清专区一区|
久久精品国产欧美成人|
一区二区不卡在线高清视频|
日韩一区三区av在线|
欧美一区二区三区久久网站|
国产精品一区91在线|
五月婷婷丁香综合|
日产精品一区二区三区免费|
亚洲,av免费在线观看网站|
亚洲激情av在线免费观看|
超碰资源人人澡麻豆精品|
国产麻豆日韩欧美|
日韩欧美视频在线播放|
国产成片免费视频app|
杨幂国产福利在线观看|
欧美一区二区三区精品|
国产日本女不卡一区|
精品 自拍 一区 在线|
欧美视频日韩专区午夜|
日韩一区二三区无|
成人在线视频一区二区三区|
日韩人妻制服丝袜|
中文字幕第一页av在线|
精品国产粉嫩一区二区三区|
麻豆精品国产三级在线观看|
精品 自拍 一区 在线|
国产精品多p对白交换绿帽|
国产一区二区三区视频|
欧美久久日韩久久亚洲精品|
国产黄av一区二区三|
中文字幕网免费在线观看|
亚洲综合色在线观看香蕉视频|
欧美国产成人免费观看永久视频|
91精品在线免费观看|
在线观看国产视频一区二区三区|
麻豆福利精品视频
|
国产精品一区二区白嫩在线观看|
欧美日本韩国亚洲免费在线播放|
夜色视频国产欧美|
亚洲女人下面毛茸茸湿漉漉|
国产美女18毛片水真多|
国产午夜三区视频在线|
国产尤物视频在线观看.|
国产精品久久久不卡天堂视频|
日本精品视频一区二区三区不卡|
久久er99视频精品|
国产老女人精品视频网站|
日本一二三区视频|
少妇午夜av一区二区三区|
91香蕉大神在线观看|
亚洲男人精品视频在线观看
|
婷婷了五月色香综合缴情|
欧美一区二区三区精品|
日日夜夜天天综合久久|
久热字幕在线播放av|
中文字幕在线观看91色|
劲爆激情欧美毛片|
国产精品视频综合|
国产日韩区一区二在线观看|
欧美精品一区视频免费看|
日韩亚洲高清一区二区|
一区二区不卡资源中文在线|
国产精品日韩欧美一区二区三区在线观看
|
日韩欧美另类中文字幕免费|
91av精品在线播放|
91影院国产区在线观看|
免费视频久久久久|
日韩av综合久久久|
香蕉色综合久久综合网
|
日韩高清有码中文字幕一区二区|
日产精品成人av片免费看|
免费在线精品视频|
亚洲国产成人视屏|
国产原创在线视频|
日韩在线一区二区视频|
美女在线免费高清av|
亚洲综合网在线观看|
亚洲片区一区二区三高清|
亚洲一区二区三区在线高清播放|
都市激情欧美日韩一区二区|
午夜精品久久久999麻豆|
久久久av一区二区三区|
日本加勒比在线一区中文字幕|
制服丝袜国产大胆自拍av|
一卡二卡三卡视频在线|
国产精品成人麻豆专区|
日韩影视成人中文字幕在线播放|
国产成人精品一区二区三区|
日韩精品久久一区二区三区|
日韩欧美在线观看一区二区三区
|
成年人看的网站免费看国产|
亚洲免费精品网站|
亚洲精品第一国产综合野草社区|
日韩精品一卡二卡在线|
亚洲第一免费久久午夜视频|
国产三级中文字幕|
看免费黄色一级视频|
欧美一区在线观看视频的|
午夜乱码在线观看一区二区
|
婷婷综合伊人狠狠|
男女免费啪啪网站无遮挡|
国产成人一二三区|
国产综合精品日韩欧美亚洲一区|
亚洲欧洲国产精品|
精品一区二区三区高清在线|
在线观看中文字幕第一页第一页|
天天影视色香欲综合网老头|
亚洲成熟毛多妇女av毛片
|
亚洲欧美另类国产校园自拍一区|
日本欧美午夜精品一区二区
|
日韩国产麻豆精品搜索在线观看|
亚洲日本韩国一区二区在线|
粉嫩av一区二区三区粉嫩|
日韩午夜激情一区二区|
亚洲欧洲美洲日产国产|
国产在线写真福利视频|
精品欧洲视频一区二区三区|
国产91久久久久久久免费|
亚洲一区二区三区高清|
最新欧美日韩国产一区二区三区|
99精品国产成人观看免费不卡|
精品一区二区中文字幕绝色|
激情久久丁香婷婷|
一本一道午夜精品久久久久久|
日韩一区二区久久久|
国产色视频网站免费观看|
欧美成人全部免费|
亚洲av黄片一区二区三区|
欧美日韩国产成人综合在线|
久久伊人麻豆综合|
91精品国产综合成人|
婷婷色香九月综合缴情|
久久亚洲精品成人av大尺度|
黄色影院一区二区三区久久久|
欧美国产一区在线观看视频
|
日韩区一区视频在线观看不卡|
欧美曰韩精品免费观看视频
|
欧美一区二区三区大爽粗|
国产欧美成人一区二区三区|
九九热国产精品视频|
亚洲女人下面毛茸茸湿漉漉|
日韩欧美专区一区|
亚洲韩国日本欧美一区二区三区|
日本一二三精品黑人区|
伊人久久大香线蕉综合影院首页|
精品国产精品中文字幕|
亚洲欧洲精品一区二区三区精品|
国产欧美日韩精品一二三区|
日韩欧美影视一区二区三区|
在线免费观看成人不卡视频
|
91欧美精品成人综合在线观看|
日韩高清一区二区三区五区七区|
日本韩国在线网站|
欧美一级黄片免费在线视频|
成人亚洲视频在线观看|
国产a三级三级三级|
中文字幕视频一区二区在线观看|
手机在线中文字幕国产精品|
麻豆精品视频在线观看91|
在线观看国产一区二区视频|
日韩人妻精品一区二区在线|
国产日韩欧美成人|
日本人成视频免费一区二区|
欧美一区二区三区午夜尖叫|
欧美一区二区三区白人|
成人精品动漫视频在线观看|
国产高清露脸自拍视频在线观看|
国产精品久久午夜夜伦|
国产精品久久久成人av电影|
成人在线观看国产亚洲精品|
精品视频免费一区二区三区|
欧美日本一道本免费三区|
中文字幕第一页视频观看|
亚洲天堂最新网址|
中文字幕在线一区免费观看|
欧美亚洲综合图区在线|
日韩午夜激情一区二区|
国产亚洲色片在线播放|
国产精品久久久熟女|
亚洲熟妇成人精品一区蜜臀
|
91久久青青草原免费|
一区二区三区四区亚洲视频在线|
国产一级一级国产|
亚洲国产人久久久成人精品网站
|
精品免费看一区二区三区婷婷
|
欧美一区二区福利视频|
国产女人在线观看|
精品国产乱码久久久久酒店|
久久综合伊人77777|
久久 激情 国产|
午夜神马福利免费官方|
日韩欧美成末人一区二区三区|
亚洲中文字幕久久国产综合|
久久蜜臀麻豆人妻一区二区三区
|
欧美a级视频在线免费播放|
日韩欧美熟女视频一区二区三区|
中文字幕日本人妻久久免费|
超碰资源人人澡麻豆精品|
成人羞羞漫画羞羞首页|
nu77亚洲综合日韩精品|
国产成人精品自产拍在线观看|
久久人妻精品国产一区二区|
日韩伦理在线一区二区三区|
久久国产成人免费视频|
午夜精品蜜桃久久|
国产伦精品一区二区三区在线观看|
亚洲精品精华液一区|
日本韩国在线网站|
国产男女猛烈视频在线观看的人|
欧美亚洲日本韩国在线观看|
日本免费一区不卡在线中文|
99精品成人高清在线观看|
日本一区二区免费播放视频|
欧美高清一区二区三区欧美|
中文字幕在线高清免费|
久久午夜激情视频|
亚洲动漫精品一区二区三区
|
国产精品中文字幕一区二区|
国产首页亚洲精品在线看|
日本久久久久久久久久久
|
夜夜嗨老熟女av一区二区三区|
国产精品伦一区二区三区视频|
欧美日韩精品久久久久|
国产精品午夜波多野结衣性色|
欧美三级在线视频麻豆|
韩国av永久免费 韩国成人禁片在线观看|
欧美国产日韩观看|
日韩91av在线观看|
久久综合日韩亚洲精品色|
欧美午夜久操视频播放在线观看
|
国产福利在线观看一二三|
精品久久久久久久久久国产小说|
99视频有精品视频在线观看|
久久综合一区二区精品视频|
久久影视中文字幕一区|
欧美午夜片欧美片在线观看|
丰满激情久久av一区二区三区|
日韩中文在线一区二区三区|
国产午夜免费啪啪视频|
久久久久点国产精品免费看|
日韩不卡的视频在线观看|
久久久久国产精品人|
一本色道久久久888|
色伊伊网在线观看免费网站|
九九国产在线视频|
国产成人精品久久av|
国产人成免费视频|
综合久久综合久久|
国产精品18久久久白浆|
欧美日韩亚洲三区|
欧美理论片在线播放|
欧美日韩国产丝袜一区|
日本一区二区最大胆a级视频|
免费黄色激情网站在线观看|
亚洲av免费网址在线观看|
黄色免费在线一区二区三区|
不卡视频精品在线免费观看
|
在线观看日本动漫|
成av人一区二区三区久久|
久久久久久亚洲女同第一区暖暖|
日本免费网站视频www区不卡|
一区二区三区精品痴汉电车|
欧美日韩午夜在线看|
欧美a级毛欧美1级a大片99|
都市激情动漫精品视频亚洲一区
|
www69日本免费一区二区|
国产成人精品一区二区三区的|
综合自拍亚洲综合图不卡区|
国产亚洲精品在a线观看|
国产成人精品在线|
91午夜亚洲精品一区|
色综合色狠狠天天综合色hd|
亚洲国产韩国一二三区|
精品日韩久久国产av大片|
中文字幕午夜精品久久久|
久久久久综合中文字幕|
久久久自慰白浆91精品一|
激情日韩丝袜亚洲精品欧美|
欧美在线播放一区二区久曰|
熟女二区国产91大香蕉熟女一区|
最新午夜综合福利视频|
国产精品一区二区三区在线|
婷婷综合伊人狠狠|
亚洲欧美日产综合在线网|
丝袜诱惑久久免费|
精品久久久久久久久久一区二区|
国产妇女性爽视频免费|
久久久久久久久av免费观看|
久久综合国产精品一区二区|
亚洲国产成人不卡电影网站
|
国产精品久久午夜福利|
好男人社区精品视频在线观看|
国产成人精品亚洲777图片|
国产高清综合乱色视频免费|
韩国日本免费高清观看|
国产午夜影院一区二区三区|
国产一区视频在线|
手机看片国产免费永久|
日本一区二区三区高清一道免v|
国产精品视频网站你懂得|
国色天香天天影院综合网|
欧美激情精品久久999|
国产成人一二三区|
在线免费观看国产黄色av|
中国做爰国产精品视频|
亚洲一区二区三区 第四页
|
国产在线视频 欧美|
毛片tv1区三区四区免费观看|
婷婷丁香久久久久|
丝袜诱惑久久免费|
日本在线播放亚洲一区|
一区三区欧美国产精品一区|
国产在线观看免费人成短视频|
91麻豆视频官网|
日韩一级片在线免费观看|
亚洲免费精品网站|
欧美xxx视频一区二区三区|
免费一级淫片日本高清视频一
|
日韩国产一区二区三区片|
久久久久成人黄片|
亚洲人成免费网站|
99综合中文字幕在线视频|
性做久久久久久蜜桃花|
色天天综合色天天天天看大
|
日本人体一区二区|
一区二区三区成人在线观看|
一区二区三区视频观看一区|
久久精品影院麻豆|
极品少妇内射在线视频精品|
欧美国产日本视频|
一级片黄色视频九九久久|
人妻午夜一区二区三区四区|
热久久国产最新地址获取|
精品成人18亚洲av下载|
青青青青草原国产免费|
国产午夜亚洲精品理论片不卡|
欧美日韩精品视频免费观看|
一区二区三区不卡免费视频9|
久久久国产精品福利一区|
国产精品日韩欧美制服|
欧美成年人激情片免费在线观看|
91精品在线观看中文|
日本成人精品视频一区二区三区|
日韩高清一级毛片一区二区|
国产精品老女人精品视频|
国产精品一区二区手机看片|
欧美福利在线精品国产|
久久大香香蕉国产免费网站|
免费一级淫片日本高清视频一|
久久99国产伦子精品免费|
色综久久综合桃花网|
.日本美女久久久精品视频|
国产精品夜夜拍拍一区二区|
亚洲淑女精品一区二区三区|
久久久国产亚洲一区二区|
欧美激情一级精品国产|
欧美日韩一区久久久久久|
亚洲高清不卡在线视频免费观看|
午夜精品一区二区三区四区|
欧美国产日本韩国一区二区|
国产噜噜噜噜在线精品|
国产欧美一区二区视频在线观看|
亚洲一卡二卡av高清网页|
视频 国产 日韩 欧美|
超碰人妻在线一区二区|
福利一区二区三区在线视频|
亚洲国产成人精女人久久久|
久久久国产精品福利一区|
欧美 日韩 亚洲 区 在线看|
国产精品福利久久久久久小说|
好男人社区精品视频在线观看
|
欧美午夜激情一区|
最新更新盗摄国产系列精品亚洲|
亚洲黄色影片在线观看|
成av人一区二区三区久久|
日韩av熟妇婷婷激情|
国产精品一级一片视频|
成人国产精品久久久久久亚洲|
欧美一区二区三区午夜尖叫|
久久午夜福利久久网|
五月婷婷激情久久久深深爱|
亚洲欧美国产日韩在线观看|
精品粉嫩国产一区二区三区|
毛片在线看免费日韩|
国产91精品在线免费观看|
亚洲天堂中文字幕2021|
久热字幕在线播放av|
国产成人精久久久久999|
一区日韩二区欧美三区国产|
国产亚洲中文久久网久久综合|
亚洲精选午夜视频在线观看|
视频在线观看日韩欧美|
久久久毛片免费全部播放|
亚洲一区二区三区 视频在线
|
亚洲香蕉av一区二区三区|
国产一区二区视频在线视频观看|
成人亚洲视频在线观看|
亚洲国产一区二区在线|
91精品刘玥在线播放|
国产又粗又长免费观看视频|
亚洲国产精品www在线观看|
成人午夜免费视频免费看|
日本一二三四五区中文字幕|
综合久久久久久中文字幕|
日本精品一区二区三区在线观看|
最刺激黄a大片免费观看下载|
久久国产性感美女视频|
国产在线观看免费人成短视频|
少妇特黄一区二区三区美国毛片|
天堂va亚洲va日本va|
国产日本女不卡一区|
中文字幕免费看一区二区三区|
亚洲一区二区三区 第四页
|
成人免费公开视频|
国内揄拍国内精品视频|
久久精品视频在线播放|
亚洲成人黄色av天堂|
久久国产精品综合|
日本韩国美国另类免费观看|
在线观看日本动漫|
正在播放国产精品视频|
欧美日韩亚洲二区在线|
1313午夜精品美女爱做视频|
国产成人亚洲精品免费观看|
欧美一区二区不卡视频在线观看|
国产 精品 欧美 在线|
91欧美一区二区在线视频|
久久精品国产亚洲av久久久|
国产一区二区精品三级馆|
蜜臀久久久亚洲精品国产|
亚洲国产一区二区精品专区发布潘金莲
|
国产免费怕怕免费视频观看|
国产一区二区福利小视频|
午夜亚洲精品视频|
亚洲第一影院一区二区三区|
99综合之综合久久伊人
|
亚洲一区二区三区精品视频|
欧美激情亚洲色图中文字幕|
快色视频一区二区在线观看|
亚洲精品岛国一区二区三区|
国产97精品一区二区在线播放|
国产精品国产三级国产专业不|
日本黄色大片在线播放视频免费观看
|
国产又黄又爽的刺激视频|
92国内揄拍国内精品人妻|
亚洲一区二区三精品在线观看|
欧美一级在线视频|
国产成人自产拍视频在线观看|
丰满少妇大力进入av亚洲|
欧美日韩国产亚洲一区二区|
女同精品一区二区三区在线播放器|
日本亚洲欧美一区二区三区在线观看|
老司机精品免费在线观看|
国产亚洲精品啪啪视频|
亚洲欧美国产激情视频网|
在线国产成年人看的网站|
黄色国产精品一区二区三区
|
免费乱舔的视频网站观看|
青青草原国产免费av|
精品v亚洲v欧美ⅴ高清v 精品v亚洲v欧美v高清v 精品v欧美v亚洲v高清v 欧美高清v日韩v亚洲综合
|
日本高清免费不卡在线观看|
亚洲国产精品www在线观看|
日本深夜福利视频在线播放|
日韩不卡的视频在线观看|
色欧美亚洲一区二区三区|
在线观看网站国产|
久久久精品久久久久特色影视|
国产男女黄视频在线观看|
性色av不卡一区二区三区|
丰满人妻被公侵犯久久久|
久久人妻一区二区三区免费密臀|
亚洲人妻av免费在线免费播放|
一区二区三区欧美高清视频|
99久久夜色精品国产亚洲va|
日本人体一区二区|
国产在线一区二区三区在线观看
|
奇米一区二区三区四区久久|
国产在线视频 欧美|
婷婷色在线视频中文字幕|
免费观看日本伦理电影|
日韩精品一区二区三区电影在线|
在线免费观看成人不卡视频|
麻豆果冻传媒精品二三区
|
成人福利在线观看免费视频|
在线观看欧美日韩黄|
精品久久久久蜜臂色欲av|
国产在线激情观看|
久久综合av免费观看|
国产一区二区三区av无|
欧美精品一区二区三区免费播放|
国产精品91一区二区在线
|
久久精品久久精品国产大片|
亚洲特色一级视频|
国产成人教育视频在线观看
|
国产精品一亚洲av日韩av欧|
欧美日韩一区天堂|
国产精品对白交换绿帽视频|
亚洲精品国产伊人|
国产精品日本久久|
亚洲日本韩国一区|
日本五十路一区二区三区在线观看|
亚洲女人av久久天堂|
五月天精品视频在线观看|
国产91久久久久久久免费|
久久国产乱子伦精品免费台湾
|
精品一久久香蕉国产欧美综合|
天天影视色香欲综合网老头|
亚洲女人国产香蕉久久精品|
欧美成人在线免费|
国产九九在线免费观看|
国产高清视频在线观看二区|
欧美日韩港台一区二区三区|
丝袜av式人一区区三区|
色欧美亚洲一区二区三区|
国产人在线成免费视频观看|
中文国产日韩精品av片|
一本一道午夜精品久久久久久|
国产精品久久久久aⅴ福利|
国产在线视频一区二区三区不卡|
日本成人色一区二区三区|
久久在线免费视频|
精品一区二区三区成人不卡视频|
免费人妻久久久久|
欧美日韩一区二区中文成人|
深夜福利成人免费在线观看
|
91香蕉大神在线观看|
亚洲av午夜福利一区二区国产|
中文国产成人精品久久下载|
国产av成人专区一区|
午夜伦伦影理论片大片|
亚洲国产精品一卡二卡三卡|
国产精品制服丝袜第一页|
97精品国产福利一区二区三区|
日韩欧美亚洲精品一区|
亚洲天堂福利久久|
欧美视频在线观看你懂得|
亚洲男人的天堂网站www|
久久精品一区二区三区四区|
国产精品欧美成人久久|
粉嫩av一区二区三区在线观看
|
91精品国产自产在线丝袜啪
|
暖暖在线中文免费韩国|
日本性感丝袜女秘书诱惑|
久久久久久ww美女大香蕉
|
91精品国产91久久综合|
久久国产精品啪99|
99国产在线播放|
在线观看国产欧美精美视频|
亚洲国自产一区二区夜夜嗨av|
亚洲精品国产熟女久久久麻豆
|
中文字幕网免费在线观看|
欧美又粗又长又爽做受|
久久久成人免费视频|
精品一级片久久久久|
免费的日本成年x片在线视频|
欧美一区二区另类|
天堂在线观看亚洲视频不卡|
久久久一级黄色综合视频|
国产精品久久久久岛国欧美|
精品精品视频在线免费观看|
91免费福利精品国产|
精品女同一区二区三区不卡|
欧美午夜福利片在线|
中文字幕在线观看第一页日韩|
国产人成免费视频|
国产精品久久久熟女|
欧美桃色视频在线免费观看|
人妻av日韩精品一区二区三区|
亚洲国产精品一区二区三区久久|
日本,国产,欧美综合在线|
国产一二三区久久久|
日本高清一区二区三区高清视频|
日韩欧美中文字幕一区二区|
亚洲最大av免费在线观看|
欧美国产日三级视频|
日韩中文欧美在线|
超97视频在线观看国产日韩|
亚洲av免播放器在线播放|
国产在线写真福利视频|
国产精品18久久久白浆|
国产精品日本一区二区不卡视|
精品国产suv一区二区|
欧美午夜久操视频播放在线观看|
亚洲嫩草影院一区二区三区|
久久精品五月天色综合|
国产精品久久久久久亚洲伦理
|
欧美午夜福利片在线|
亚洲成人国产综合|
久久久久综合中文字幕|
日韩中文欧美亚洲|
91国精品产品一区二区三区|
亚洲一区二区三区视频在线看|
久久精品影院麻豆|
男女啊啊啊免费视频网站|
日韩精品特级一区二区三区|
亚洲精品一卡二卡免费在线观看|
亚洲一区二区三区四区视频|
伊人久久大香线蕉综合影院|
日本一区二区成年人网站|
国产精品亚洲精品|
亚洲欧美一区二区久久婷婷|
最新av中文字幕在线
|
国产日韩欧美高清一区二区精品
|
日本一二三四五区中文字幕|
欧美日韩国产高清视频在线观看|
亚洲精品一区二区三区区别
|
东京热高清一区二区三区|
91精品全国免费观看含羞草|
五月天丁香婷婷一区二区伊人
|
伊人久久大香线蕉综合影院首页
|
亚洲中文字幕精品久久久久久|
成年人看的网站免费看国产|
免费一级欧美大片在线观看|
色婷婷中文字幕久久久|
久久人妻中文系列|
国产成人一区二区|
国产欧美视频专区|
91超碰97精品在线观看|
精品污污免费网站|
日本在线激情免费播放不卡|
国产在线一区二区三区免费观看|
九九久久精品国产|
久久精品久久精品国产大片|
国产中文欧美字幕|
日本爱爱一区二区|
成人一区二区三区视频观看|
久热字幕在线播放av|
亚洲精品韩在线观看视频|
日本精品一区欧美|
日韩在线播放网址|
国产黄色大片在线观看|
国产成人av专区一区|
日日噜噜噜噜人人爽日本精品|
亚洲国产成人综合|
国产欧美日韩综合视频在线观看|
欧洲特一级黄色视频|
国产在线观看免费一大av|
成年人看的网站免费看国产|
日本女优免费一区|
亚洲乱熟妇一区二区三区蜜臀|
日本二道本一区视频在线观看|
欧美性与交视频在线观看|
久久97久久99久久综合欧美|
亚洲又色又爽又黄又大视频|
国产麻豆日韩欧美|
亚洲国产成人久久综|
欧美日韩一本二本在线播放|
人妻少妇猛烈插入中文字幕|
国内精品一区二区三区视频|
国产精品玖玖玖在线观看|
精品女同一区二区三区不卡|
久久综合九九亚洲一区|
久久老色鬼天天综合网观看|
国产一区二区伦理视频|
精品日本久久久久久人妻日本|
久久人妻精品不卡|
亚洲欧美日韩中文v在线|
亚洲欧美国产视频二区|
成人欧美亚洲国产电影|
国产av一区二区三区三区|
亚洲韩国日本在线视频一区|
一区二区激情在线观看|
国产精品视频一区二区三区不卡|
日韩av片免费播放|
青青青青久久国产片免费精品|
人人爽人人做人人爱av|
欧美精品国产日韩|
青草香蕉精品视频在线观看
|
免费成人亚洲电影|
日本中文字幕在线精品|
亚洲精品网站免费|
日本成年人网站在线观看|
久久激情视频精品视频|
亚洲 国产 91|
欧美日韩理伦一区二区三区|
国产精品久久久久aⅴ福利
|
另类欧美亚洲综合|
亚洲精品国产伊人|
国产婷婷综合丁香亚洲欧洲|
日本一区不卡在线观看视频|
免费视频久久久久|
一区二区三区在线区在线播放|
av一区二区高清在线|
国产亚洲欧美成人91|
欧美成人午夜福利在线视频|
欧美日韩港台一区二区三区|
欧美日韩第一区在线观看|
好爽又高潮了大片免费观看|
国产精品视频综合|
国产黄色大片在线观看|
亚洲国产日韩在线观看一区|
大杳蕉伊人狼人久久一本线|
精品中文字幕人妻一区二区
|
看片欧美日韩在线|
一区二区三区四区五区午夜福利
|
亚洲视频免费观看一区二区三区|
小明永久成人一区二区|
久久久日韩午夜精品大全|
热久久国产最新地址获取|
国产一区二区伦理视频|
亚洲欧美日韩精品护士|
亚洲系列免费在线观看不卡|
国产精品va一级二级三级|
亚洲精品国产啊女成拍色拍|
在线看国产一区二区三区一|
午夜视频在线观看国产片不卡|
国产十八禁美女视频网站免费|
久久一区二区av影院|
免费一高清一区二区视频|
欧美视频在线观看你懂得
|
五月婷婷伦理综合亚洲|
国产高中生视频在线观看|
中文字幕日韩电影亚洲电影|
久久蜜臀麻豆人妻一区二区三区|
国产日产欧美一区二区视频|
亚洲精品岛国一区二区三区|
欧美精品久久一区二区三区|
日韩欧美视频在线播放|
亚洲国产欧美日韩在线精品一区|
国产中文久久精品|
日韩区一区视频在线观看不卡|
日本深夜福利视频在线播放|
欧美 韩国 日本 一区|
国产日产欧美一区二区视频|
国产精品制服丝袜第一页|
欧美日韩亚洲国产综合|
天堂在线观看亚洲视频不卡|
色黄视频在线观看|
在线观看国产一区二三区|
国产制服av在线网|
亚洲中文字幕精品久久久久久|
国产精品欧美精品中文字幕|
国产午夜亚洲精品理论片不卡|
91精品国产91久久久久福利|
亚洲欧洲美洲综合在线|
日韩影视成人中文字幕在线播放
|
日本不卡人一区二区最新视频|
亚洲欧洲精品国产|
久久久久久看美女精品|
大香蕉五月婷婷精品视频|
亚洲精品一二三区久久久|
亚洲 国产 91|
精品人妻av中文字幕在线|
国产首页亚洲精品在线看|
精品人妻高清一区二区三区|
国产男女黄视频在线观看|
亚洲日本乱码在线|
人人干人人妻超碰人人爽|
亚洲精品国产乱码av在线观看|
久久久久点国产精品免费看|
日韩综合亚洲欧美|
国产v欧美v日韩v在线观看|
欧美黑人一级爽快片淫片视频|
欧美一区二区三区激情电影在线|
国产不卡在线高清视频免费v
|
91精品国产自产在线观看福利|
在线观看的黄色av网址|
2022国产精品永久在线|
在线视频中文字幕第三页|
亚洲国产欧美人成|
欧美熟妇另类久久久精品|
亚洲黄色视频天堂网|
日本在线一二三区|
亚洲成人国产综合|
激情欧美日韩一区二区|
久久精品国产亚洲av久|
国产婷婷久久久久久久|
亚洲精品一区久久狠狠欧美|
日韩精品一区二区电影|
亚洲精品日韩激情在线电影|
日韩欧美亚洲精品电影一二区|
国产精品麻豆一区二区|
日韩欧美在线观看高清视频|
国产女主播视频一区二区三区|
日本人妻中文字幕有码在线视频|
日日噜噜噜噜人人爽日本精品|
综合国产av一区二区三区|
欧洲精品一区二区三区|
狠狠躁91三区二区一区|
国产成人啪精品视频网站|
日本激情戏一区二区三区|
欧美一二三区视频免费观看|
国产男女猛烈视频在线观看的人|
精品视频午夜一区二区|
国产黄色在线免费观看|
久久久精品美女av在线观看|
午夜福利在线观看av|
精品 自拍 一区 在线|
亚洲国产精品免费线观看视
|
久久国产精品久久国产精品|
成人午夜av国产精品|
麻豆精品国产熟妇aⅴ一区|
欧美三级一级视频在线播放|
欧美视频一区二区三区精品|
国产精品亚洲天堂av|
成人黄色毛片视频|
亚洲一区二区三精品在线观看|
不卡无吗在线视频快速播放|
成人三级av网站在线观看|
伊人在亚洲精品网|
精品国产青青在线观看爽香蕉|
亚洲第一区二区三区精品|
日本中文字幕在线精品|
日韩美女一区二区三区|
欧美午夜在线成人|
午夜久久精品一区日韩|
天天操夜夜操国产av|
美女高潮久久免费观看一区精品|
国产一区二区三区在线|
国产欧美日韩精品一二三区
|
亚洲第一页在线播放|
国产精品69re在线观看免费|
欧美精品v欧洲在线观看|
日韩中文在线一区二区三区|
亚洲欧洲美洲综合在线|
国产91精品欧洲在线观看
|
亚洲精选免费视频|
国产拍拍拍拍拍拍拍拍拍拍拍拍拍|
日本亚洲视频免费在线|
日本,国产,欧美综合在线|
暖暖高清视频日本中文www
|
亚洲国产精品一区二区三区久久|
91精品啪在线国产81|
在线免费观看日本伦理电影|
日韩av综合久久久|
亚洲欧美综合一区二区三区四区
|
久久久亚洲精品乱码|
久久成人在线播放视频|
欧产日产国产一区|
午夜福利在线观看av|
男人插女人视频网站免费|
日韩亚洲欧美中文在线网|
精品久久久久久人妻视频|
亚洲精品乱码久久久久久麻豆不卡|
毛片在线观看一区二区|
亚洲免费一区二区三区视频|
欧美成人精品不卡视频在线观看|
国产99精品免费视频|
96久久久久人妻精品专区|
国产自产免费一区二区三区|
欧美成人家庭影院|
亚洲国产成人精女人久久久|
国产在线精品一区二区三区国…|
成人中文字幕在线免费观看|
亚洲综合七月色婷婷在线播放|
黄色一级视频免费|
www日本成人一区精品|
久久久精品美女av在线观看|
日韩欧美视频手机在线观看|
欧美在线视频一区免费观看|
亚洲精选午夜视频在线观看|
黄色视频在线免费看亚洲|
香蕉视频亚洲一级|
国产成人欧美一区二区三区|
99久久精品一区二区三区|
99精品成人高清在线观看|
久久久久久久午夜免费毛片|
国产原创av在线 免费播放成人一区二区三区四区|
中文字幕乱码一区二区三区免费
|
欧美美女午夜视频|
亚洲国产人久久久成人精品网站|
亚洲影视av在线一区二区三区播放|
www69日本免费一区二区|
欧美日韩中文字幕精品|
人人爽人人做人人爱av|
综合国产av一区二区三区|
欧美视频一区二区三区精品|
欧美视频 国产视频|
日本韩国一区二区网站在线观看|
精品视频一区二区三三区四区|
日本高清不卡视频免费观看|
国产精品萌白酱在线观看|
深夜影院深a久久|
久久综合中文97人人爽|
亚洲欧美黄免费在线观看|
日本的精品免费在线播放|
香蕉精品视频一区二区三区|
国产成人久久av免费高清蜜臀|
亚洲天堂中文字幕2021|
日本免费一区二区三区四区|
日韩精品免费在线观看|
日本免费完整版观看|
国产成人亚洲精品动漫|
免费视频成人在线观看
|
免费观看久久av 久久av免费播放
国产永久免费高清在线观看视频
2022国产精品永久在线
|
少妇久久久中出中文字幕|
国产精品婷婷久青青原|
久久黄色视频免费的|
91超碰97精品在线观看|
日本欧美国产精品第一页久久|
日韩一区二区午夜久久|
精品国产乱码一区二区三区久久|
中文字幕在线高清免费|
亚洲国产成人久久一区久久|
日韩一级欧美一级国产|
国产一区视频免费在线观看h
|
欧美色精品人妻视频在线|
亚洲欧美另类中文字幕|
成人在线观看网站|
国产精品成av人在线视午夜片|
91精品久久久久久中文制服|
91琪琪丝袜国产在线观看|
丁香午夜六月婷婷激情|
亚洲一区二区三区在线现观看
|
大杳焦伊人久久综合热|
国产精品欧美日韩在线一区二区
|
国产精品久久久久三一级|
成人在线视频亚洲一区二区
|
国产无吗一区二区三区在线欢|
男人桶女人下面久久久精品|
成人免费观看一级黄色片|
日本一区二区三区四区五区|
欧美aaaaa精品午夜福利 成人动漫精品一区二区三区四区
|
国产丝袜一区二区三区免费观看|
91久久青青草原免费|
老司机精品一区在线视频|
91免费福利精品国产|
国产精品久久综合激情|
精品一区二区三区久久|
手机在线观看国产精选免费|
国产精品免费香蕉视频网|
黄色一级片高清国产精品|
丁香亚洲精品国产一区|
国产首页亚洲精品在线看|
精品视频久久久久久久久|
91影院国产精品|
欧美激情在线亚洲综合|
欧美国产亚洲二区|
国产成人av免费影视|
久久精品亚洲毛片美女极品视频|
ⅹⅹⅹ黄色片视频|
欧美日韩经典中文字幕|
国产高清亚洲精品26u|
久久久精品久久久久特色影视|
网曝门精品国产事件在线观看|
免费不卡一区二区三区视频|
国产直播一区二区三区|
亚洲av官网一区二区三区|
亚洲天堂第一中文av|
在线国产成年人看的网站|
老司机精品视频在线观看69|
亚洲日本午夜福利在线|
久久久久国产精品人|
国产日产欧美视频在线播放|
新中文字幕第一页在线观看视频|
日本夜爽爽爽一区二区三区|
人妻夜夜操一区二区三区|
国产丝袜一区二区三区免费观看|
正在播放国产精品视频|
亚洲欧洲美洲一区二区三区|
精品一区二区三区小黄片|
92精品成人国产在线观看|
国产小视频在线免费|
av在线免费最新观看|
久久99国产伦子精品免费|
暖暖高清视频日本中文www
|
久久久久点国产精品免费看|
国产精品视频综合|
大香蕉一区在线观看|
国产人久久人人人人爽|
国产日韩久久久精品影院首页|
亚洲综合日韩久久成人av|
久久综合国产精品一区二区|
欧美日韩在线播一区二区三区|
黄色av手机在线观看|
日韩毛片一区二区三区免费播放|
久久久av一区二区三区
|
国产一级a爱看片免费视频|
国产福利中文字幕在线观看
|
欧美黄片精品二区|
免看**一片成人123|
国产一区二区三区精品不卡|
高清精品一区二区|
国产精品 欧美视频 日韩|
亚洲国产一区二区三区四|
国产精品高潮vv|
福利视频在线观看午夜|
日本成人精品视频一区二区三区|
欧美日韩一区二区三区自拍|
不卡一区二区高清免费视频|
成人黄色免费在线视频|
亚洲av日韩精品久久久久久久|
亚洲免费www在线观看|
亚洲精品一区二区三区综合|
久久网站免费视频|
91人妻丝袜久久精品|
亚洲欧美黄免费在线观看|
久热字幕在线播放av|
国产成人免费黄色|
久久久成人一区二区三区|
手机在线中文字幕国产精品|
91精品福利电影天堂在线|
精品国产乱码一区二区三区久久|
欧美视频一区二区三区在线
|
国产麻豆一区欧美|
精品日本久久久久久人妻日本|
成人久久久久久免费观看|
成人精品一区二区三区中文字幕|
免费一级特黄日韩大片|
国产爆乳福利视频|
日韩精品一区二区在线观看视频|
国产精品日本一区二区在线播放|
欧美午夜不卡视频在线观看|
狠狠色综合图区久久久久久|
一区二区三区视频资源在线观看|
色婷婷中文字幕精品|
伊人在亚洲精品网|
日韩欧美在线观看一区二区三区|
日本亚洲欧美一区小视频|
毛片在线看免费日韩|
亚洲午夜手机在线免费观看|
日韩在线字幕免费中文版|
国产精品一区二区手机看片|
蜜臀一区二区三区不卡少妇|
视频在线观看 一区二区
|
91麻豆精品激情在线观看最新|
精品欧美激情精品一区蜜桃|
欧美日韩一区二区中文成人|
蜜臀久久97精品久久久久久|
亚洲精品经典自拍|
亚洲日本韩国一区二区在线|
成人午夜免费小视频网站|
www.日本乱码一区二区三区|
久久亚洲国产成人精品小说|
日本在线播放视频www|
成人一区二区视频在线播放|
亚洲综合七月色婷婷在线播放|
性高湖久久久久久久久AAAAA|
亚州国产av一区二区三区伊在|
久久综合伊人77777|
国产精品国产三级野外国产|
色哟哟视频在线一区二区三区|
中文字幕日韩av电影网|
成人伦理电影免费|
久久精品影院区二区三区|
亚洲aaa精品视频在线观看|
人妻少妇av中文字幕乱码|
男人和女人毛片免费观看高清|
成人影院欧美大片免费看|
国产97精品在线观看|
亚洲专区中文字幕|
国产一级av免费播放|
国产欧美精品福利|
久久人人超97人妻香蕉免费|
一级日本特黄毛片视频|
,天天爽夜夜爽夜夜爽精品视频
|
女人的高潮无遮挡国产av|
亚洲国产精品成人av在线观看
|
欧美午夜久操视频播放在线观看|
亚洲精品字幕一区二区三区|
国产欧美一区二区三区在线看|
成人免费观看一级黄色片|
欧美一区二区三区激情电影在线|
日本一区二区三区少妇视频|
国产成人色视频一区二区三区
|
精品国产大片久久久久久久久
|
中国做爰国产精品视频|
免费播放巨茎人妖不卡片|
激情 另类 国产|
日本一区二中文欧美视频|
国产大片欧美精品|
一本色道综合久久|
激情社区一区二区在线免费观看
|
国产精品久久精品久久|
日本一区二区三区免费播放|
欧美一区二区另类|
欧美午夜片欧美片在线观看|
人人人狠人人爽天天综合网|
国产男女黄视频在线观看|
亚洲国产成人视屏|
日本一区二区中文字幕播放|
久久久欧美国产精品人|
国产极品大乳在线观看|
国产成人另类亚洲欧美日本|
国产成人在线亚洲|
日韩中文有码高清|
精品久久久久久久免费加勒比
|
午夜精品一区二区三区四区|
亚洲精品成人免费|
91在线成人观看|
国产精品亚洲天堂网|
国产,欧美,日韩在线视频|
国产视频久久综合|
亚洲国产日韩欧美中文高清视频|
亚洲一区二区三区 第四页
|
在线欧美日韩精品一区二区
|
男人的天堂久久久久久久久久
|
天堂av 日韩在线|
国产又粗又黄又黑的视频免费看|
亚洲二三区免费在线观看|
91精品国产高清久久久久|
精品久久久久久人妻视频|
日本成人一二三区|
日韩av一区二区免费在线|
日韩av一本二本在线观看|
久久伊人中文字幕麻豆|
福利视频在线观看午夜|
午夜福利电影日韩|
久久精品成人免费国产片桃视频|
成人黄色视频网站在线|
久久久久久看美女精品|
看好看日本不卡中文视频在线|
激情欧美一区二区三区中文字幕|
日韩欧美专区一区|
亚洲中文一区二区日日骚|
亚洲精品www视频在线观看|
日本不卡一区二区视频在线|
日本欧美午夜精品一区二区|
国产免费看网站v片不遮挡|
精品午夜国产在线观看不卡|
婷婷丁香综合亚洲激情|
黄色一级视频免费|
日本一区二区最大胆a级视频|
色国产在线视频一区|
自拍 亚洲 午夜 福利|
久久久婷婷中文字幕|
久久精品视频在线播放|
国产不卡在线高清视频免费v
|
国产在线视频一区二区三区不卡|
视频 国产 日韩 欧美|
99在线精品国自产拍中文字幕|
99精品久久久中文字幕|
国产亚洲精品在a线观看|
另类欧美亚洲综合|
一卡二卡日韩人妻|
国产,欧美,日韩在线视频|
久久亚洲国产成人精品小说|
久久精品老司机老女人视频|
午夜区一区二区三在线观看|
国产毛卡片在线观看|
精品美女一区二区三区四区|
亚洲一区二区三区精品视频|
手机在线中文字幕国产精品|
久久精品影院区二区三区
|
欧美精品久久久一二三区优播|
又黄又爽又免费又刺激视频网站|
亚洲欧美动漫卡通另类bt|
亚洲精品电影久久久影院|
我想看亚洲aⅴ成人a级片.|
成人免费公开视频|
国产黄色免费在线观看网站|
国内精品久久人妻一区二区三区|
亚洲精品一卡二卡免费在线观看|
激情五月久久亚洲综合|
亚洲欧美日韩国产高清无毒|
亚洲视频一区二区三区蜜臀|
成人精品人成网站|
中国av日韩av免费免费|
在线看不卡的av网站|
五月天丁香婷婷一区二区伊人|
在线观看视频中文字幕一区二区|
中文字幕综合在线免费视频|
国产av一区二区三区绯色|
中文字幕性av在线|
国内揄拍国内精品视频|
亚洲激情高清免费|
免费va国产精品小视频|
久久人做人爽一区二区三|
精品国产粉嫩一区二区三区
|
国产中字幕不卡一区|
欧美 日韩 在线 综合|
黄片国产精品下载|
国产成人一区二区三区精东
|
最新中文字幕久久|
中文字幕第一页视频观看|
91久久伊人精品青青草原
|
中文字幕在线观看视频第二页|
色爱av综合网国产精品|
国产精品高潮呻吟久久av号码|
另类欧美亚洲综合|
高清中文字幕在线观看网址
|
亚洲免费成人女人|
欧美在线成人高潮国产|
国产精品成人一区二区三区电|
国产又黄又爽的刺激视频|
精品污污免费网站|
亚洲国产av成人精品成人|
欧美日韩色黄大片在线视频|
国产成人精品亚洲日本在线桃色|
99热国产一区二区在线观看|
亚洲一级免费毛片|
亚洲欧美日韩精品护士|
99精品国产综合久久久五月天|
蜜臀久久97精品久久久久久|
91精品国产自产在线丝袜啪|
亚洲韩国日本欧美视频91|
欧美日韩一区二区中文成人|
国产福利视频在线观看|
欧美日韩一区二区高清视频大全|
91九色精品国产免费|
国产拍拍视频一二三四区|
国产成人精品专区|
日本一区二区激情视频在线观看|
91精品在线免费观看|
永久免费看毛片一区二区|
超级碰碰青草久热国产|
亚洲一区二区久久久久品区|
中文av在线字幕观看|
日本免费一区二区三区四区|
91美女在线播放|
午夜性激福利免费观看|
91影院国产精品|
国产91在线播放九色0|
午夜男女毛片在线视频|
日韩高清在线久久|
国产91精品欧洲在线观看|
麻花精品国产一区二区三区av|
亚洲国产人久久久成人精品网站|
免费毛片一区二区三区四区|
粉嫩av一区二区三区在线观看|
亚洲欧洲日韩一区二区三区四区五区
|
av久久免费观看 久久av免费观看|
99热这里只有免费国产精品|
久久国产午夜福利大片|
亚洲国产欧美日韩在线精品一区
|
在线免费观看日本视频高清|
欧美一级日韩中文字幕18|
日韩中文字幕第七页|
中文字幕第8页在线资源|
欧美成人特级一区二区三区|
成人伦理电影免费|
亚洲高清日韩专区|
日本人成视频免费一区二区|
久久99精品久久久久久齐|
亚洲国产成人精女人久久久|
国产精品视频网站你懂得|
久热国产精品视频|
欧美日韩精品午夜久久国产|
欧美日韩国产精品91久久|
久久久,av色综合|
日韩欧美最新免费在线观看视频|
三级久久久久久久久高潮|
日韩欧美在线电影|
国产午夜激情视频|
欧洲精品在在线观看|
一本到午夜92版免费福利|
亚洲欧美日韩久久中文字幕|
久久久久久国产成人精品|
国产视频在线欧美|
国产精品欧美性色|
色综合久久天天综合绕观看
|
精品乱码无人区一区二区|
婷婷综合五月激情|
国产成人精品亚洲777图片|
国产丝袜一区二区三区免费观看|
国产精品黄色小视频|
久久亚洲福利视频|
在线观看国产成人av天堂野外|
欧美日韩国产精品激情在线播放|
日本午夜福利日韩免费|
久久av日韩午夜福利片|
男女啊啊啊免费视频网站|
天堂av 日韩在线|
日本激情视频免费观看网站|
亚洲国产精品人久久电影|
99久久国产日韩一区二区|
国产成人精品一区二区视频|
成av人一区二区三区久久|
自拍 亚洲 午夜 福利|
精品午夜国产在线观看不卡|
久久久久久一区二区三5区|
国产三级在线观看播放|
日本美女视频一区二区三区四区
|
国产免费一级成人av|
成人18在线观看一区|
亚洲成人午夜福利精品在线观看|
久久亚洲男人第一av网站色性|
99热国产一区二区在线观看|
欧美激情精品久久久高清|
午夜福利影院免费在线观看|
国产成人av三级在线又见|
欧美一级黄片免费在线视频|
欧美大片全集免费播放
|
久久精品私人影院免费看|
亚洲日本一区二区三区不卡不码|
日韩欧美一区在线观看|
www.蜜桃久久久|
av一区二区在线观|
偷拍三级久久精品|
最新亚洲欧美日韩|
日本黄色高清中文字幕在线播放|
欧美日韩第一区在线观看
|
中文字幕国产1区|
国产精品成人一区二区三区电|
久久老熟女一区二区三区福利
|
欧美国产亚洲二区|
国产h在线视频观看免费|
免费的中文字幕在线视频|
精品视频一区二区三区四区涩爱|
日韩午夜精品免费理论片|
中文字幕日韩av电影网|
欧美日韩一区天堂|
免费看18级做a爰片久久|
欧美激情在线播放国产精品|
国产精品国产三级在线专区
|
国产精品日韩欧美制服|
久久综合九九亚洲一区|
国产三级精品一区二区不卡
|
成人在线刺激av 午夜久久鲁蜜影院
|
色婷婷中文字幕久久久|
欧美一区二区激情视频|
欧美亚洲日本国产一区三欧美|
亚洲欧美黄免费在线观看|
亚洲欧美国产高清va在线播|
都市激情动漫精品视频亚洲一区|
亚洲精品一二三区在线免费观看|
99r视频国产在线观看免费|
亚洲成人免费一区二区三区|
欧美三级一区二区三区|
欧美一区二区三区日本|
偷拍三级久久精品|
粉嫩av一区二区三区在线观看|
国产视频福利在线|
亚洲欧洲国产精品|
日韩制服亚洲中文字幕版|
日本一区不卡在线观看视频
|
日本成人精品视频一区二区三区
|
亚洲成年电人电影网站|
四虎永久在线精品国产免费|
国产成人亚洲综合a∨婷婷|
99久久精品国产一区二|
国产成人久久精品一区二区三区|
最新av中文字幕在线|
国产精品麻豆91|
熟女女同亚洲女同中文字幕|
久久黄色视频免费的|
中文字幕久久最新|
精品v亚洲v欧美ⅴ高清v 精品v亚洲v欧美v高清v 精品v欧美v亚洲v高清v 欧美高清v日韩v亚洲综合
|
国产欧美原创视频在线观看|
国产一区二区欧美视频在线观看
|
精品一区两区视频在线观看|
亚洲成人大片在线免费观看|
深夜影院深a久久|
久久精品国产无限资源|
国产欧美另类性视频|
欧产日产国产一区|
国产日韩欧美高清一区二区精品
|
亚洲综合国产一二三四五区|
日本高清免费的不卡视频|
国产一级一级国产|
日韩欧美精品国产精品|
亚洲国产精品三级在线观看|
欧美成人全部免费|
99在线精品国自产拍中文字幕|
不卡一区二区三区在线免费观看|
国产成人久久精品一区二区三区|
欧美乱人伦精品一区二区|
亚洲毛片日韩一区二区|
欧美一区在线观看视频的|
欧美久久日韩久久亚洲精品|
国产亚洲精品久久精品6|
精品人妻一区二区久久九九|
国产直播一区二区三区|
亚洲视频免费观看|
成人免费视频播放|
香蕉视频亚洲一级|
亚洲欧美日韩影片|
四季av不卡在线播放|
国产视频在线观看一区二区|
亚洲一区二区三区 第四页
|
国产大陆亚洲精品国产|
欧美成人肉肉视频在线观看
|
九九久久精品国产|
国产日韩在线观看一级|
手机在线观看国产精选免费|
色黄视频在线观看|
精品视频免费一区二区三区|
中文字幕精品久久久久边|
美女在线免费高清av|
欧美 日韩 国产 综合网|
一卡二卡国产三卡四卡乱码日韩|
亚洲精品视频永久免费在线观看|
国产一区二区三区精品不卡|
国产中文字幕五月天|
国产精品 欧美激情91|
五月婷婷综合激情在线|
亚洲欧美另类国产校园自拍一区|
国产日韩亚洲精品在线播放|
久久99精品视频一区97|
在线观看的黄色av网址|
国产亚洲av成人久久精品
|
日韩中文欧美在线|
91精品国产自产在线丝袜啪|
国产精品免费看视频|
亚洲激情欧美激情|
国产精品久久久久三一级|
91精品国产自产在线观看福利|
国产成人精品一区二区视频|
在线免费观看国产精品黄片|
日本高清视频在线www色不卡|
久久人人人人澡人人澡|
久久精品国产无限资源|
青青久久精品国产免费看夜夜嗨|
国产一卡二卡三卡在线看|
日韩精品在线成人一区二区|
久久久久免费国产视频|
精品久久86一区二区三区av|
亚洲欧美激情综合第一页|
精品一级片久久久久|
亚洲av综合网在线观看|
亚洲一区二区三区视频在线看|
欧美日韩亚洲国内|
日韩激情欧美大片一区二区三区
|
一级二级三级毛片|
少妇被又大又粗又爽毛片久久黑人|
国产成人91精品一二三区|
在线免费观看国产黄色av|
久久影视中文字幕一区|
欧美日韩第一区在线观看|
一区二区三区视频在线观看午夜|
日本高清一区二区三区在线观看|
亚洲电影日产精品视频一区|
国产成人久久av免费看|
日日噜噜噜噜人人爽日本精品
|
国产精品亚洲精品日韩已满|
99久久精品一区二区三区|
日本黄色免费网站|
成人毛片高清视频观看|
中文字幕日产乱码偷在线|
欧美日韩精品午夜久久国产|
欧美国产成人精品一区|
深夜福利成人免费在线观看|
99久久精品国产一区二|
台湾成人性视频免费播放|
欧美日韩一区二区三区久久|
日韩精品久久在线观看|
亚洲成人三级在线观看|
成人欧美性生交大片免费看|
熟女女同亚洲女同中文字幕
|
日本女优免费一区|
中文字幕av一区在线|
国产av自拍不卡一区二|
91欧美一区二区在线视频|
欧美日本视频在线|
免费一级欧美大片在线观看|
免费观看精品视频|
亚洲欧美成人另类丝袜|
国产精品久久精品福利网站|
黄色av网站午夜久久|
成人精品动漫视频在线观看|
人人人夜夜夜精品视频网站|
国产极品视频久久久|
日本高清免费不卡在线观看
|
国产亚洲精品综合|
久草视频国产在线观看00|
国内午夜国产精品小视频|
精品一区二区三区久久|
日韩欧美亚洲综合久久影院|
最新欧美日韩在线观看视频|
亚洲欧美清纯丝袜另类|
亚洲高清日韩专区|
激情欧美一区二区三区中文字幕|
久久成人一区二区|
国产老熟女精品久久久久影院|
久久中文字幕免费久久中文|
国产精品久久午夜夜伦|
国产在线成人一区二区|
91成人在线视频|
亚洲免费一区二区三区视频|
国产尤物视频在线免费观看|
欧美精品一区二区三区中文字幕|
国产日产高清欧美一区|
成人亚洲国产精品中文字幕一区|
欧美成人一区二区在线播放视频|
日韩欧美一区在线观看|
国产高清亚洲精品26u|
亚洲天堂欧美综合|
国产人成久久久精品|
国产乱淫av麻豆国产|
国产人成久久久精品|
久久久午夜福利精品|
成人午夜福利红桃视频|
精品欧美国产一区二区三区|
中文影院不卡一区二区三区|
麻豆精品91福利在线|
亚洲欧洲国产av综合|
国产视频在线观看一区二区|
精品一区二区三区视频免费观看|
少妇高潮久久久久|
视频在线观看 一区二区|
成人久久伊人精品伊人|
一级a爱片久久A毛片天天|
国产不卡av中文字幕|
久青草国产在视频在线观看|
人人妻人人做人人爽91精品
|
蜜桃国内精品久久久久软件|
日本欧美午夜精品一区二区|
日本免费一级a在线播放|
亚洲精品中文字幕9999|
在线看不卡的av网站|
人妻夜夜操一区二区三区|
亚洲欧美日韩国产高清无毒|
日本美女中文字幕第一区
|
国产精品视频网站你懂得|
国产三级精品三级在专区中文|
在线国产成年人看的网站|
日本一区二区最大胆a级视频|
日本换爱交换乱理伦片|
黄色一级免费视频|
国产精品久久综合激情|
欧美精品综合一区二区三区|
亚洲国产日韩在线人高清|
都市激情动漫精品视频亚洲一区|
日本成人 在线播放|
国产精品大秀视频福利一区二区|
亚洲精品成人午夜福利在线|
久久亚洲国产成人精品小说|
亚洲国产精品久久影院|
日韩精品特级一区二区三区|
国产高清露脸自拍视频在线观看|
日韩免费成人av电影网站|
中文字幕久久最新|
久久黄色视频免费的|
日韩一级毛一欧美一级毛免费|
一区二区三区不卡免费视频9|
91精品视频88av在线观看|
午夜精品播放视频一二三区|
亚洲 中文字幕偷拍|
亚洲精品一区久久狠狠欧美|
国产精品三级三级看三级|
日本一级淫片日本高清小说|
亚洲女人天堂在线|
日本韩国台湾三级黄色视频|
看久久久久久中文三区毛片|
国产一区二区三区调教视频|
日本免费高清视频|
欧洲精品在在线观看|
制服丝袜美腿一区二区三区波多|
真实国产乱子伦一区二区|
欧美桃色视频在线免费观看|
亚洲一区男女那个的视频网站|
欧美成视频在线观看|
亚洲国产精品官网|
正在播放国产一区,二区|
精品女人视频三区|
国产女同真实视频在线观看|
激情欧美日韩国产在线观看|
91精品产国品一区|
亚洲免费精品网站|
欧美色噜噜精品一区二区三区|
日日噜噜噜噜人人爽日本精品|
91精品国产91久久久久久黑人|
久久99久久99精品免观看|
欧美一区二区三区日韩在线|
青青久久精品国产免费看夜夜嗨
|
国产亚洲精品久久久久久|
国产成人在线观看网站|
99久久超级视频免费观看|
国产精品欧美综合|
国产中文字幕尤物在线|
国产在线精品福利91香蕉|
日韩毛片一区二区在线观看|
少妇高清精品毛片在线观看
|
伊人在亚洲精品网|
99久久精品国产一区二|
在线视频亚洲精品|
中文日韩欧美亚洲|
欧美国产综合视频在线观看
|
成年人午夜在线观看网站|
亚洲国产精品人久久电影|
日韩精品视频在线播放免费|
精品久久久一区二区|
日韩精品欧美激情在线观看视频|
亚洲精品国产乱码av在线观看|
66色免费观看亚洲欧洲精品|
亚洲精品国产乱码av在线观看
|
日韩中文字幕人妻精品|
一区二区三区国产高清免费视频|
欧美三级在线观看黄|
国产精品国产三级野外国产|
91精品福利电影天堂在线|
福利成人午夜国产一区|
2021日韩亚洲第一页|
在线免费观看亚洲男人的|
国产精品久久精品福利网站|
国产在线观看免费人成短视频|
亚洲免费精品视频|
国产免费一区二区三区www
|
日韩av电影免费在线观看|
日韩免费电影观看高清|
美女诱惑av在线观看|
丝袜诱惑久久免费|
99在线精品国自产拍中文字幕|
日韩欧美在线观看一区二区三区
|
国产一级一级国产|
日韩欧美另类中文字幕免费|
91伊人色伊人亚洲综合网站|
性做爰欧美电影在线观看|
亚洲精品视频在线免费观看不卡|
人妻中文字幕一区二区免费线|
国产精品亚洲午夜一区二区三区
|
国产av高清中文字幕
|
成人中文字幕在线免费观看|
在线观看一区二区三区不卡|
欧美一级视频在线免费播放|
福利一区二区三区在线视频|
久久桃色激情开心丁香婷婷
|
精品国产综合区久久|
日本丶国产丶欧美色综合|
久久午夜激情小视频|
夜夜嗨久久国产精品综合网|
快色视频一区二区在线观看|
日韩在线一区二区在线一区|
热久久精品视频三级视频|
欧美字幕日韩欧美一区二区|
成人精品免费视频|
国产日韩亚洲精品在线播放|
国产精品制服丝袜第一页|
欧美aaaaa精品午夜福利 成人动漫精品一区二区三区四区
|
免费观看美女福利视频一区二区|
aaaa欧美激情在线观看|
国产精品视频久久久久|
日本视频一二三区|
久久久婷婷中文字幕|
亚洲国产手机精品在线观看|
日韩亚洲国产中文|
日韩人妻中文字幕黄色av|
亚洲欧美日韩久久中文字幕|
亚洲午午夜夜久久电影|
色婷婷中文字幕久久久|
最新国产三级久久|
国产在线精品一区二区三区国…|
欧美a级视频在线免费播放|
黄色视频在线免费看亚洲|
久本草在线中文字幕亚洲|
丰满少妇被猛烈进入在线放|
欧美日韩高清免费视频|
日本成人 在线播放|
欧美视频亚洲视频高清在线|
亚洲av免费网址在线观看|
日韩免费一区二区|
一级av国内在线观看|
中国少妇久久一区二区|
亚洲精品少妇视频在线观看|
欧美激情欧美精品欧美色妇
|
中文字幕在线一区二区三区|
亚洲一区二区三区欧美精品|
国产成av人在线免费观看|
亚洲日本在线免费观看|
国产精品女教师久久二区二区|
国产色视频网站免费观看|
国产亚洲精品一区二区电影|
国产 精品 欧美 综合 在线|
男女男国产精品视频入口|
高清一区二区三区视频免费|
超碰人妻在线一区二区|
久久久成人一区二区三区|
欧美激情精品久久久高清|
亚洲精品久久久日韩美女高清|
日本 人妻 三级 在线|
欧美污视频一区二区在线观看|
久久中文字幕在线观看|
亚洲激情av网站在线观看|
国产激情免费一区二区三区|
国产精品日韩久久肉色丝袜交足|
国产一区视频免费在线观看h
|
高清中文字幕在线观看网址
|
小明永久成人一区二区|
久久国产在线观看|
国产在线播放一区二区|
亚洲天堂视频一区|
国内精品久久久久久久久|
日本免费一区不卡在线中文|
在线一区中文字幕国产|
老司机精品视频在线观看69|
国产精品视频网站你懂得|
免费在线观看av网站国产|
国产在线精品一区二区网站|
亚洲国产欧美啪啪自拍|
综合久久给合久久狠狠|
久久不卡亚洲一区二区三区|
国产在线一区二区三区免费观看|
国产精品污双胞胎在线观看|
欧美福利在线精品国产|
国产精品日韩亚洲成人|
国产极品大乳在线观看|
国产原创在线视频|
亚洲精品www久久久久久下|
国产精品一区91在线|
国产精品久久久成人av电影|
手机看片国产免费永久|
日本在线播放视频www|
美女被爆羞羞网站视频免费|
久久在线免费视频|
四季av不卡在线播放|
欧美日韩国产丝袜一区|
欧美久久一区日韩精品午夜国产
|
欧产日产国产精品精品|
国产图片日韩欧美亚洲|
国产精品久久久久桃色tv|
成人乱码一区二区三区四区|
亚洲视频欧美视频在线观看|
香蕉视频在线观看亚洲91|
亚洲欧洲精品一区二区三区精品|
欧美精品久久一区二区三区|
亚洲国产91最新网址|
日本在线播放亚洲一区|
日本一区二区在线视频免费观看|
日本在线高清播放|
视频 国产 日韩 欧美|
成人精品一二三区|
亚洲欧美国产激情视频网|
亚洲av综合网在线观看|
性欧美一区二区三区四区视频|
亚洲 国产 一区 在线|
亚洲五月天视频在线观看|
日韩视频在线观看免费看|
日韩一级在线观看|
国产一级在线观看视频|
亚洲精品少妇视频在线观看|
亚洲图片欧美日韩另类|
一本一道久久a久久综合精品|
日本在线观看无乱码视频|
国产亚洲欧美日韩精品综合在线|
国产精品一区二区三区影院|
成人亚洲国产视频|
国产精品久久久久久亚洲伦理|
国产精品日韩欧美一区二区三区在线观看
|
亚洲av成人一区国产精品|
99久久久国产精品免费99|
一区二区成人在线电影|
韩国日本电影中文字幕|
亚洲国产精品一二区三区|
日本高清免费在线视频|
亚洲专区中文字幕|
免费观看欧美一区二区三区|
欧美成人黄色精品|
精品 自拍 一区 在线|
a看一区二区三区视频在线观看|
欧美一区二区三区在线观看|
又湿又黄的免费视频网站|
欧美日韩成人综合在线|
久久久久免费国产视频|
91亚洲精品久久|
日本男人操爆女人视频麻豆|
欧美日韩成人高清在线播放|
国产欧美一区二区三区在线看|
久本草在线中文字幕亚洲|
91精品乱码久久久久蜜桃|
日韩av熟妇婷婷激情|
日韩欧美视频在线播放|
成人三级av网站在线观看|
日本成人色一区二区三区|
一区二区三区四区五区午夜福利|
亚洲精品一区二区三区观看|
夜色视频国产欧美|
日本爱爱www视频在线观看|
日韩精品久久久九九九|
国产亚洲a v人片在线观看|
少妇午夜av一区二区三区|
免费网址视频在线看|
三级黄色毛片午夜|
亚洲午午夜夜久久电影|
亚洲国产手机精品在线观看|
国产九九在线免费观看|
久久中文字幕免费久久中文|
欧美国产日韩电影|
日韩国产麻豆精品搜索在线观看|
日本成人影在线观看国产精品|
国产在线播放观看|
久久久久成人黄片|
国产福利精品视频|
欧美日韩成人综合在线|
色欲综合一区二区三区|
色国产在线视频一区|
爱福利在线国产精品福利一区|
男女啊啊啊免费视频网站|
福利视频在线观看午夜|
99在线精品国自产拍中文字幕|
国产不卡在线高清视频免费v|
久久se一区二区|
中文字幕在线不卡国产视频|
欧美日韩国产在线偷|
国产肉丝美女久久|
一区二区欧美日韩高清免费|
国产视频二区在线观看|
国产欧美视频专区|
亚洲欧洲美洲综合在线|
激情婷婷亚洲丁香|
国内午夜国产精品小视频|
久久夜色撩人精品国|
欧美日韩亚洲国内|
成人久久伊人精品伊人|
国产精彩亚洲中文在线不卡|
97国际精品在线视频播放|
精品亚洲中文视频在线观看|
麻豆成人永久久久|
国产日韩欧美一区二区三区三州|
亚洲经典一区二区三区四|
日韩欧美在线观看|
欧美一级日韩中文字幕18|
久久综合中文97人人爽|
国产视频久久综合|
国产精品入口免费视频一|
国产一区二区午夜嘿嘿嘿|
一区二区三区国产精品|
免费又黄又爽又猛大片午夜|
69视频免费在线观看|
亚洲视频在线观看成人免费|
欧美国产综合成人在线电影|
国产精品18亚洲|
欧美久久一区日韩精品午夜国产|
伊人久久五月天综合网|
国产日产欧美一区二区视频
|
久久精品夜色国产亚洲av|
欧美成人高清在线观看网址|
国产精品毛片一区视频|
亚洲精品丝袜国产字幕久久
|
国产性生活一级片|
亚洲精品字幕一区二区三区|
国产成人www免费人成看片|
日本一区二区在线视频免费观看|
欧美性与交视频在线观看|
亚洲国产中文一区|
久久国产精品综合|
国产欧美日韩精品一二三区|
国产av一区二区三区三区|
国产视频午夜精品|
av在线免费看天堂不卡|
亚洲黄av网站在线观看|
粉嫩av一区二区三区在线观看|
国产午夜麻豆影院在线观看|
国产精品高颜值在线观看|
自拍 欧美 日韩 在线|
国产综合精品在线观看91|
91精品福利电影天堂在线|
国产精品日韩亚洲成人|
国产成人精品专区|
91精品福利电影天堂在线|
欧美一级毛片久久99精品蜜桃|
夜色视频国产欧美|
久久精品欧美一区二区
|
国产欧美视频专区|
人人爽人人做人人爱av|
国产欧美日韩伦中文|
亚洲v国产v欧美v综合精品|
日本二道本一区视频在线观看|
欧美精品一区视频|
亚洲一区二区三区四区a v|
亚洲欧美国产高清va在线播|
91人妻丝袜久久精品|
少妇一区二区三区久久|
日本人体在线免费不卡视频|
亚洲精品久久久久久久久久久中文字幕
|
亚洲欧洲国产精品|
亚洲欧美国产激情视频网|
日本韩国国产在线播放网|
露脸国产自产拍在线观看|
日韩高清一区二区三区五区七区|
欧美xxx视频一区二区三区|
欧美国产亚洲免费在线观看|
中文字幕精品在线观看|
国产精品免费在线一区二区|
国产极品视频久久久|
久久狠狠一本综合|
欧美在线成人高潮国产|
国产在线视频网站|
中文字幕制服丝袜国产精品|
性欧美一区二区三区四区视频
|
国产日产成人亚洲综合毛片|
久久精品视频影院|
韩国美女毛片视频免费观看|
日韩裸体大尺度av一区|
蜜桃久久久精品免费视频|
国产美女久久久免费视频|
亚洲免费成人播放视频大全|
国产精品第一区在线观看|
夜夜爽一区二区三区视频|
男女免费啪啪网站无遮挡|
一级黄色录像在线观看|
台湾成人性视频免费播放|
国产在线播放观看|
国产男人午夜视频在线观看|
综合狠狠综合久久综合|
91精品福利电影天堂在线|
www.欧美日本在线观看|
狠狠综合久久久综合网|
人人澡人人爽人人妻欧美一区|
成人亚洲国产视频|
日韩一区二区精品久久久|
欧美日韩一区天堂|
91香蕉视频 在线|
乱人伦中文视频在线|
中文字幕第一页在线播放|
韩国精品视频在线观看|
中文字幕日产乱码偷在线|
毛片在线观看视频一区二区|
日本黄色影片久久|
国产高潮呻吟网站在线观看|
日本久久久久久久久久人妻视频|
精品一级片久久久久|
欧美日韩国产高清视频在线观看
|
国产av午夜中文字幕|
亚洲国产精品人久久电影|
欧美一级特黄高清视频|
亚洲精品美女视频|
日本免费无遮挡羞禁漫画|
国产成人精品亚洲日本在线桃色|
97色偷拍一区二区三区|
久久久久亚洲av成人人|
乱人伦中文视频在线|
久久免费手机视频|
亚洲成人区一区二区三区|
国产精品白丝护士av在线网站|
欧美一区二区三区四区久久|
亚洲国产人久久久成人精品网站|
成人免费公开视频|
综合色区亚洲熟妇另类a|
久久亚洲精品中文字幕二区|
国产亚洲av片天天在线观看人|
日韩欧美一级毛片视频免费|
久久老熟女一区二区三区福利
|
国产ts在线播放|
一区二区三区四区亚洲欧美|
免费观看黄片亚洲|
久久99久久99精品免观看|
久久精品国产亚洲av成人乐播|
久久久不卡一区二区三区|
日本高清视频在线www色不卡|
国产拍拍拍拍拍拍拍拍拍拍拍拍拍
|
国产成人不卡刺激视频在线观看|
麻豆国产在线视频|
欧美亚洲精品一区二区三区|
久久久久久美日韩视频|
国产在线精品一区二区三区国…|
欧美一区二区三区视频视频|
欧美内射小视频在线观看|
国产精品爽爽久久久表情|
久久久精品欧美日韩国产|
一区二区欧美日韩高清免费|
国产精品丝袜在线观看一区二区|
日本爱爱www视频在线观看|
国产成人久久av免费高清蜜臀|
色哟哟视频在线一区二区三区|
国产精品久久久熟女|
自拍 欧美 日韩 在线|
久草视频国产在线观看00|
一卡二卡国产三卡四卡乱码日韩|
中文字幕一区婷婷久久|
国产成人自拍视频免费在线观看|
亚洲欧美综合一区在线观看|
麻豆精品国产熟妇aⅴ一区|
麻豆久久精品影院|
欧美精品国产精品中文字幕|
国产精品国产三级野外国产|
欧美日韩视频在线第一区二区三区|
黄色一级片一区二区|
欧美色精品人妻视频在线|
亚洲精品成人午夜影院在线观看|
九九久久精品国产|
国产av午夜中文字幕|
国产蜜臀av一区二区在线观看|
国产色婷婷99在线视频观看|
亚洲国产精品一二区三区|
日本高清视频一区二区三区四区
|
日本精品久久久久一区的电影|
日韩视频精品一区|
中文字幕xxx日韩在线|
亚洲欧美中文国产|
91精品隔壁老王在线观看|
亚洲人成网站在线在线观看|
人妻aⅴ一区二区三区色戒乐|
欧美视频一区二区三区网站|
av在线免费最新观看|
毛片在线观看一区二区|
欧美不卡的一区二区三区
|
欧美日韩精品久久久久|
日韩精品视频卡一卡二免费|
成人精品一二三区|
美国毛片一级视频在线aa|
在线观看日韩视频免费观看|
午夜91精品视频国产|
最新最好看中文字幕在线播放|
欧美日韩国产一区久久|
国产十八禁美女视频网站免费
|
精品一区二区三区高清在线|
日韩欧美另类中文字幕免费|
69视频免费在线观看|
久久免费精品性猛交蜜桃
|
亚洲国产成人精女人久久久|
国产成人欧美一区二区三区|
日韩一区二区三区最黄免费观看|
日韩人妻中文字幕精品|
欧美日韩国产另类视频|
日本一区二区三区免费播放|
日韩一级毛一欧美一级乱|
成人18在线观看一区|
日本东京热久久成人免费电影
|
免费国产成人高清在线视频|
91视频精品一区|
国产不卡在线观看一区二区三区|
欧美精品综合一区二区三区
|
五月婷婷综合基地|
国产男女做受高潮毛片一级|
国产成人aⅴ片在线观看免|
午夜成私人影院在线观看|
欧美激情视频网站免费观看|
欧美午夜久操视频播放在线观看|
欧美大欧美乱码一二三四区|
国产成+人综合+亚洲专区|
国产中文亚洲精品|
欧美国产成人免费观看永久视频|
日本成年人网站在线观看|
99精品又爽又大又硬少妇毛片|
亚洲综合日韩久久成人av|
欧美国产日本韩国一区二区|
日韩人妻系列不卡|
亚洲精品字幕一区二区三区|
亚洲午夜视频免费观看|
久久日韩欧美精品综合久久|
精品新一区二区三区四区|
日本亚洲欧美一区小视频|
中文字幕一区二区三区乱码借种|
久久精品美女视频|
欧美一级专区免费大片|
欧美三级黄色片在线观看|
日韩av片免费播放|
美国毛片一级视频在线aa|
亚洲激情网在线免费观看|
久久桃色激情开心丁香婷婷|
亚洲欧美激情日韩在线|
久久久久久综合久久伊人|
国产色片自拍视频|
欧美国产亚洲二区|
在线观看国产一区二三区|
a看一区二区三区视频在线观看|
91伊人色伊人亚洲综合网站|
欧美激情精品久久999|
国内精品久久久久影院日本|
国产网红主播在线诱惑av|
一级黄色录像在线观看|
久久国产视频这里有精品|
国产嫩草一区二区三区观看在线
|
国产免费看网站v片不遮挡|
一本一道午夜精品久久久久久|
日韩欧美亚洲激情图片视频|
黄色一级片高清国产精品|
成年人免费在线观看国产精品|
日韩视频在线播放网址大全|
日韩精品极品在线观看视频|
欧美一区二区三区日本|
在线观看欧美日韩黄|
国产福利美女诱惑|
欧美日韩港台一区二区三区|
国产欧美日韩中文久久|
国产图片日韩欧美亚洲|
国产精品视频网站你懂得|
欧美一线二线三线毛片|
欧美字幕日韩欧美一区二区|
国内成人免费视频|
欧美亚洲精品一区二区三区|
亚洲综合成人在线视频|
精品视频午夜一区二区|
亚洲天堂男人天堂|
精品动漫在线观看视频一区|
日韩免费一区二区|
欧洲精品在在线观看|
欧美蜜臀一区二区三区四区|
精品久久久久久人妻视频|
国产精品91一区二区在线|
国产精品,亚洲精品免费|
五月婷婷伦理综合亚洲|
国产精品制服丝袜第一页|
欧美国产一区二区不卡视频|
韩国日本电影中文字幕|
一区二区三区国产精品保安
|
免看**一片成人123|
美国成人毛片亚洲社区|
在线免费观看久久久www.|
..久久国产精品视频,久久|
97成人在线观看免费视频|
91深夜福利免费观看网站|
日韩欧美一级毛片视频免费|
久久成人午夜免费电影|
欧美日韩素人在线观看|
国产男女性做爽歪歪爱视频|
中文字幕日韩av电影网|
亚洲人成电影在在线观看网色|
91精品国产自产在线观看福利|
免费又大粗又爽又黄少妇毛片|
黄三级高清在线直播|
国产精品v欧美精品超碰天堂|
亚洲人在线观看视频不卡|
国产成人av专区一区|
亚洲韩国日本欧美一区二区三区|
日本成人精品视频一区二区三区
|
国产视频一区精品|
亚洲欧美成人另类丝袜|
国产中文字幕第5页|
国产精品性色av一区二区|
欧美色欧美亚日韩在线视频|
久久99精品视频一区97|
色婷婷综合一区二区在线播放
|
日韩欧美三级一区二区在线观看|
亚洲欧美国产高清va在线播|
最近韩国日本免费播放大全|
人妻少妇猛烈插入中文字幕|
国产精品一区二区免费|
欧美日韩一区二区中文字幕|
日韩一级毛一欧美一级a免费|
欧美高清一区二区三区欧美
|
手机在线观看国产精选免费|
欧美精品久久久久久综合网|
国产高清视频一区二区在线观看|
亚洲av片大全在线观看|
在线观看精品一区二区|
一区二区三区在线区在线播放
|
亚洲精品午夜视频|
亚洲精品小说一区二区|
九九电影国产精品午夜福利|
亚洲乱码一区二区三区香蕉下载
|
中文字幕精品在线观看|
亚洲精品动漫一区二三区在线观看|
91九色精品国产免费|
一级a一级a爰片免费网站|
亚洲激情av在线免费观看|
亚洲 国产 91|
日本免费播放视频一区二区三区
|
欧美在线视频一区免费观看|
日韩精品在线免费观看中文字幕|
日韩精品视频卡一卡二免费|
国产成人久久av免费看|
日韩不卡一卡二卡|
欧美一二三区视频免费观看|
午夜久久久久久久影院免费观看|
欧美精品一区二区三区免费播放|
亚洲一区二区三区av在线|
国产精品多p对白交换绿帽|
一本色道久久久888|
999国内精品在线观看|
丁香午夜六月婷婷激情|
国产婷婷久久婷婷|
国产精品视频网站你懂得|
欧美乱人伦精品一区二区|
国产,欧美,日韩在线视频|
日本黄色一级片免费看|
国产成片免费视频app|
狠狠色噜噜狠狠色综合久|
久久综合九九亚洲一区|
狠狠综合久久亚洲电影|
亚洲激情网在线免费观看|
国产麻豆一区欧美|
国产亚洲精品久久久一区网站|
丰满人妻被公侵犯久久久|
欧美午夜在线成人|
在线永久免费观看的毛片|
粉嫩av一区二区三区在线观看|
久久黄色国产精品一区视频|
国产精品一区二区三区影院|
国产精品第一区在线观看|
欧美日韩在线成人专区|
av电影天堂国产一区|
三级欧美国产在线观看|
久久国产精品啪99|
亚洲精品小说一区二区|
欧美日韩亚洲在线|
黄色片免费在线播放|
欧美字幕日韩欧美一区二区|
久久精品a国产亚洲v高清不卡
|
在线观看视频日本一区二区|
国产亚洲欧美日韩综合综合二区|
亚洲欧美精品中文一区二区三|
国产精品视频一区二区三区四|
欧美激情视频网站免费观看|
成人福利免费视频|
伊人久久亚洲精品一区|
蜜桃国内精品久久久久软件|
日本三级公交车理论电影|
国产偷窥2013在线视频|
日本高清免费不卡中文字幕|
五月婷婷综合在线观看视频|
2021日韩亚洲第一页|
欧美乱人伦精品一区二区|
欧美这里只有精品|
国产,欧美,日韩在线视频|
亚洲专区路线一路线二天美|
精品国产一区二区三区日日嗨
|
国产av日韩av天堂一区二区三区
|
老司机精品福利在线资源|
中文字幕精品在线观看|
国产亚洲精品久久久久久
|
国产精品综合91|
亚洲韩国日本欧美一区二区三区|
久久精品在线观看高清免费|
亚洲一区二区波多野结衣|
亚洲第一精品在线免费观看|
亚洲自拍另类欧美综合|
亚洲午夜手机在线免费观看|
五月天婷婷精品免费视频|
久久久国产精品福利一区|
国内欧美一区二区三区视频|
精品一区二区三区高清在线|
久久亚洲天堂精品视频|
中文av在线字幕观看|
97精品国产一区二区三区四|
国产小视频在线观看网站|
国产高跟丝袜美腿自拍国语|
中文字幕国产av第一页|
国产成人啪精品视频网站|
国产精品爽爽久久久表情|
欧美成黄片激情久久久|
久久影视中文字幕一区|
国产精品高潮呻吟久久av号码|
成人黄色毛片视频|
台湾成人性视频免费播放|
超碰资源人人澡麻豆精品|
日本一区不卡在线观看视频|
欧美国产综合视频在线观看|
久久国产乱子伦精品免费台湾|
国产日韩精品二区|
色七七久久桃花综合|
亚洲欧美国产激情视频网|
国产精品视频一区二区三区不卡|
人妻不卡精品久久|
久久99久久99精品免观看|
久久久国产精品福利一区|
亚洲欧美日本韩国|
国产一区视频免费在线观看h|
国产盗摄视频凸一区二区三区乱|
日韩视频精品一区|
国产成人精久久久久999|
国产日韩精品二区|
亚洲综合七月色婷婷在线播放|
成人乱码一区二区三区四区|
国产精品精品国产一区二区|
日韩影片中文字幕一区二区三区
|
日韩精品在线免费观看中文字幕|
亚洲中文字幕久久国产综合|
欧美三级在线视频麻豆|
国产精品视频一区二区三区不卡|
国产一区二区伊人久久|
欧美日韩一区二区高清视频大全|
国产成人久久久精品一区二区|
亚洲色图,欧美,日韩,丝袜|
在线成人国产亚洲|
久久99热久久精品99|
久久亚洲精品中文字幕二区|
日韩久久九九精品视频|
中文字幕网免费在线观看|
久久久精品人妻av|
欧美三级视频在线播放|
亚洲第一页在线播放|
毛片在线看免费日韩|
久久精品爱国产免费久久|
久久久久中文亚洲精品|
国产精品精品国产一区二区|
日韩影片中文字幕一区二区三区|
国产中文日本免费在线播放|
玖玖玖国产精品视频一区二区|
欧美一二三区视频免费观看|
久久久噜噜噜久久_久久综合|
国产精品大秀视频福利一区二区|
欧美一区二区在线视频|
亚洲欧美日韩中文字幕制服丝袜|
婷婷色在线视频中文字幕|
国产精品高潮呻吟久久粉嫩av|
99九九99九九九视频精品|
亚洲欧美清纯丝袜另类|
怡红院免费的全部视频国产a|
亚洲欧美动漫卡通另类bt|
精品gay视频在线观看|
久久久久久ww美女大香蕉|
日韩精品久久一区二区三区|
欧美成黄片激情久久久|
视频一区日韩经典中文字幕|
久久久精品视频一区|
麻豆成人在线免费播放视频网站|
日韩免费一区二区|
综合久久99久久99播放|
少妇特黄一区二区三区美国毛片|
欧美精品久久久久久综合网|
六月七月丁香啪啪激情综合|
国产极品资源在线观看|
欧美日韩一区久久久久久|
一区二区三区在线观看天堂|
久久伊人中文字幕麻豆|
国产成人精品专区|
欧美+日韩+中文字幕+国产|
亚洲天堂中文字幕2021|
精品免费久久久久国产一区小说
|
亚洲欧美日韩中文v在线|
正在播放国产一区,二区|
黄色国产精品一区二区三区|
一区二区不卡在线高清视频|
国产中国免费视频观看|
亚洲欧洲日韩视频在线|
亚洲av熟女国产一二区|
久久 激情 国产|
国产日产美产精品精品av|
一区二区激情在线观看|
偷国产99视频在线观看|
日韩大片黄色欧美大片黄色|
在线永久免费观看的毛片|
婷婷综合伊人狠狠|
欧美在线视频免费播放四区|
亚州精品美女中文字幕久久|
国产三级中文字幕|
亚洲日本在线免费观看|
日本免费专区在线观看网站|
欧美一级特黄特黄做受|
女人十八毛片一级片免费看|
精品人妻一区二区三区香蕉|
免费又黄又爽又猛大片午夜
|
日韩一区二区精品久久久|
一级二级三级毛片|
免费国产一级特黄久久|
韩国极品美女免费免毛片|
色伊伊网在线观看免费网站|
日韩国产精品视频|
国产婷婷久久久久久久|
国产精品久久久久无毒|
91精品久久久久含羞草|
国产精品久久午夜夜伦|
色综合久久久久久久久综合观看|
在线看不卡的av网站|
狠狠爱亚洲狠狠热久久|
艳妇一区二区三区av在线|
日本韩国国产在线播放网|
www.日本乱码一区二区三区|
老司机精品视频一级黄片|
成人精品视频一区二区在线|
白嫩美女久久久av午夜精品|
亚洲嫩草影院一区二区三区|
日本东京热久久成人免费电影|
精品国产91久久久久久一区黄无
|
国产精品亚洲第一区焦香
|
少妇高潮久久久精品|
国产av婷婷爽av综合|
亚洲国产一区二区α毛片|
久久高清精品视频一区二区|
国产老女人精品视频网站|
av网站在线一区二区|
午夜宅男免费完整在线观看|
国产午夜免费啪啪视频|
乱码精品一区二区三上人妻|
亚洲悠悠久久综合情|
亚洲成人免费一区二区三区|
国产亚洲午夜电影网|
亚洲高清日韩专区
|
亚洲人成网站在线在线观看|
欧美一区二区三区日韩电影|
91人妻丝袜久久精品|
白嫩美女久久久av午夜精品|
亚洲 国产 91|
在线免费观看成人不卡视频|
欧美美女午夜视频|
欧美激情一级精品国产|
国产网红主播在线诱惑av|
在线观看的黄色av网址|
国产黄色在线免费观看|
国产免费高清视频在线观看不卡|
av中午字幕在线播放|
亚洲成人三级在线观看|
国产精品视频一区二区三区四|
天堂视频在线观看一区二区三区|
中文字幕日本高清一区二区三|
在线播放亚洲美女视频网站|
精品久久久久久久久久国产小说|
亚洲一区二区三区精品视频|
国产亚洲精品久久美女|
欧美va在线观看 午夜理论三级在线观看
|
日本成人午夜在线|
99久久精品一区二区三区|
在线免费观看成人不卡视频|
国产在线视频一区二区三区不卡|
一区二区三区精品痴汉电车|
日韩成人免费在线视频|
黄色一级片高清国产精品|
视频在线欧美国产|
日韩在线高清电影|
久久久久点国产精品免费看|
久久久一级黄色综合视频|
国产欧美精品一区久久久|
免费观看久久av 久久av免费播放
国产永久免费高清在线观看视频
2022国产精品永久在线
|
欧洲日韩视频一区|
国产视频在线观看|
欧美日韩视频在线视频精品|
91久久伊人精品青青草原|
国产精品免费看视频|
亚洲综合日韩久久成人av|
日韩午夜视频一区二区三区|
日本欧美毛片一区二区|
亚洲天堂手机版在线观看|
亚洲欧美日韩成人一区二区三区|
一区二区三区成人在线观看|
亚洲一区二区三区精品国产内射|
日韩欧美专区一区|
麻豆久久99精品福利久久久|
日韩欧美亚洲综合久久影院|
日本久久香蕉一本一道|
国产av麻豆色哟哟|
激情视频在线播放综合网|
日本女优免费一区|
国产精品91在线|
日韩欧美一级毛片视频免费|
国产一级午夜在线观看|
xxxx日本免费观看视频不卡|
性做爰欧美电影在线观看|
欧美一级日韩中文字幕18|
久久国产视频这里有精品|
激情综合网五月尤物|
精品视频一区二区三区四区|
三级精品视频手机在线观看|
我想看亚洲aⅴ成人a级片.|
国产精品国产三级网站在线观看|
欧美a级视频在线免费播放|
中文精品爱久久久国产|
国产欧美高清视频va在线观看|
午夜福利美女视频在线|
一区二区三区欧美高清视频|
日本午夜福利日韩免费|
欧美视频亚洲视频高清在线|
久久亚洲福利视频|
国产精品成人一区二区三区电|
成人乱码一区二区三区四区|
国产黄色在线免费观看|
亚洲免费精品视频|
亚洲悠悠久久综合情|
亚洲五月天视频在线观看|
亚洲国产成人在线观看视频|
毛片一毛片二毛片三国产片|
欧美成人一区二区三区黑人|
国产日韩欧美一区二区三区三州|
国产色片自拍视频|
国产精品丝袜综合区另类|
亚洲欧洲日韩一区二区三区四区五区
|
午夜激情在线国产|
久久久毛片免费全部播放|
亚洲av官网一区二区三区|
男女免费啪啪网站无遮挡|
成人羞羞漫画羞羞首页|
亚洲精品中文字幕9999|
国产日本一区二三区精品|
精品国产制服丝袜高跟
|
2022国产精品永久在线|
久久美剧免费在线观看
|
亚洲一卡二卡免费在线观看
|
久本草在线中文字幕亚洲|
黄片一区二区三区久久|
久久免费手机视频|
一区日韩二区欧美三区国产|
国产婷婷久久婷婷|
国产午夜福利不卡在线秋霞秋霞|
亚洲精品国产啊女成拍色拍|
国产制服国产制服一区二区|
亚洲精品午夜视频|
日韩视频在线播放网址大全|
午夜福利99re国产精品|
欧美激情视频网站免费观看|
在线国产日韩欧美视频|
精品91自产拍在线|
久久最新免费视频6|
国产成人亚洲精品蜜芽影院|
国产不卡一二三区在线观看|
久久综合九色综合欧美图片|
日本在线激情免费播放不卡|
黄色av手机在线观看|
国产精品视频一区二区三区四|
三级国产一区二区三区高清|
欧美激情视频网站免费观看
|
国产精品伦一区二区三区视频|
日韩精品一区电影|
国产精品久久久国产盗摄蜜臀|
免费的日本成年x片在线视频|
国产成人精品在线|
欧美 日韩 亚洲 区 在线看
|
亚洲av午夜福利一区二区国产|
日本大蕉香蕉大视频在线观看|
亚洲综合七月色婷婷在线播放
|
男女啊啊啊免费视频网站|
看片欧美日韩在线|
中文字幕在线成人在线视频|
日本永久免费不卡视频在线最新|
中文字幕综合在线免费视频|
免费黄色大片视频|
欧美一二三区视频免费观看|
亚洲av官网一区二区三区|
国产男女猛烈视频在线观看的人|
黄色视屏免费在线观看|
亚洲国产人久久久成人精品网站|
国产人成视频在线观看夫妻
|
亚洲国产成人久久综|
国内精品视频免费在线播放|
国产午夜精品免费在线观看|
蜜臀avwww国产天堂|
亚洲第一大福利网站在线观看
|
国产高中生视频在线观看|
久热手机视频在线免费观看|
日韩三级免费毛片|
精品日韩久久国产av大片|
国产人在线成免费视频观看|
杨幂国产福利在线观看|
久久久久久一区二区午夜电影|
国产亚洲av片天天在线观看人
|
自拍 欧美 日韩 在线|
加勒比在线婷婷综合色|
欧美成视频在线观看|
日韩大屁股一区二区三区|
韩国美女毛片视频免费观看|
国产一区视频免费在线观看h|
蜜桃久久久久一区二区|
女人天堂网av在线中文字幕|
国产一区二区三区免费福利|
丝袜日韩亚洲一区|
亚洲成人网一区二区|
三级欧美国产在线观看|
久久高清精品视频免费播放|
粉嫩性色av一区二区三区蜜臀|
一级黄色毛片香蕉视频|
国产精品亚洲精品青青青
|
精品人妻高清一区二区三区|
国产极品黄色视频|
欧美精品久久一区二区三区
|
国产精品一区二区三区噜噜噜|
久久精品伊人老司机蜜桃视频|
日韩电影在线网站|
国产精品久久精品久久|
日韩久久久中文字幕视频|
国产日韩欧美综合在线|
国产在线一区二区三区四区五区六
|
国产精品一区二区免费|
亚洲综合色在线免费观看
|
久久中文字幕只有精品视频
|
92精品成人国产在线观看|
911精品美国片911久久久|
欧美日韩国产成人自拍视频|
国产av成人专区一区|
在线永久免费观看的毛片
|
国产一区二区自拍视频|
欧美亚洲一区在线播放|
在线成人国产亚洲|
日本理论免费高清在线视频|
国产成人一区二区三区精东|
99精品国产综合久久久五月天|
日韩毛片一区二区在线观看|
国产一区二区福利小视频|
久久黄色中文字幕电影|
国产福利视频在线观看|
中文字幕亚洲综合久久男男|
国产精品久久久国产盗摄蜜臀|
在线观看成人一区|
日本在线播放亚洲一区|
精品少妇无遮挡毛片视频|
色婷婷中文字幕久久久|
日韩三级在线观看视频|
久久成人在线播放视频|
欧洲特一级黄色视频|
亚洲人在线观看视频不卡|
国产第一页在线观看|
日本成人 在线播放|
国产一区涩涩亚洲三区|
又湿又黄的免费视频网站|
免费视频成人在线观看|
成人影院欧美大片免费看|
av中文字幕一区二区在线观看
|
国产欧美在线观看一区二区|
国产亚洲新品一区二区|
黄色一级片一区二区|
日本激情视频免费观看网站|
在线免费观看成人不卡视频|
亚洲综合七月色婷婷在线播放|
亚洲爽中文字幕在线观看视频|
免费国产黄片在线看|
亚洲成年看片在线观看男男|
日本成人大片免费在线观看|
日本人成视频免费一区二区
|
亚洲国产av成人精品成人|
亚洲欧洲日本国产观看专线|
久久中文字幕只有精品视频|
亚洲欧洲日韩一区二区三区四区五区
|
久久久自慰白浆91精品一|
亚洲国产精品官网|
国产精品免费久久久久影院|
国产一区二区三区导航|
少妇午夜av一区二区三区|
日韩在线中文字幕资源网|
日韩欧美精品国产精品|
成人福利在线观看免费视频
|
欧美一区二区视频观看|
免费播放巨茎人妖不卡片|
国产一区二区不卡|
国产中文字幕视频在线观看|
日韩av一区二区免费在线|
亚洲一区二区黄色|
日本天堂网中文字幕在线观看
|
国产一区二区三区91在线|
97se亚洲综合自在线|
久久精品影院麻豆|
成人18在线观看一区|
国产日本女不卡一区|
中文字幕久久一区二区三区|
亚洲欧美国产日韩在线观看|
日韩裸体大尺度av一区|
人妻japanese精品一区|
一级av国内在线观看|
亚洲精品www视频在线观看|
亚洲高清在线电影一区二区|
俄罗斯一级黄色毛片|
日本a级综合久久a|
午夜福利在线网址|
欧美美女午夜视频|
成年视频xxxxx在线网站|
亚洲国产成人久久一区久久|
大杳焦伊人久久综合热|
久久亚洲福利视频|
露脸国产自产拍在线观看|
麻豆亚洲av熟女国产一|
免费乱舔的视频网站观看|
91精品国产品国语在线不卡|
免费观看美女福利视频一区二区|
亚洲特级毛片黄色|
欧美一区二区三区激情电影在线|
一级黄色录像在线观看|
麻豆精品国产三级在线观看|
加勒比在线婷婷综合色|
国产午夜免费成人av|
91精品国产自产在线丝袜啪
|
国产福利在线免费|
国产人成久久久精品|
亚洲精品黄色av免费在线播放
|
av天堂资源在线亚洲精品
|
老司机精品一区在线视频|
中文字幕午夜精品久久久|
俄罗斯一级黄色毛片|
亚洲影院在线观看|
亚洲欧美日韩在线观看直播|
成人精品影院在线视频观看|
亚洲一区二区三区 第四页|
97人妻人人揉人人躁人人v|
国产日本欧美在线观看|
伊人色综合影院一区二区三区|
日韩欧美中文字幕免费在线观看|
国产成人剧情av在线|
中文字幕日韩久久一区二区|
性做久久久久久蜜桃花|
中文字幕日韩久久一区二区|
中文字幕日本人妻久久免费|
香蕉青草久久成人网|
av网站在线一区二区|
久久久国产精品一级二级三级|
综合国产av一区二区三区|
四虎影音永久精品一区精品|
亚洲一区二区三区四区视频|
国产成人精品亚洲日本在线桃色|
亚洲国产人久久久成人精品网站|
国产在线一区二区三区四区五区六|
亚洲香蕉av一区二区三区|
亚洲黄av网站在线观看|
色欲久久久精品久久久久久|
欧美黄色日韩成人|
色欲久久久精品久久久久久|
欧美黄色日韩成人|
成人久久久久久免费观看|
国产不卡在线观看一区二区三区
|
亚洲美女毛片在线视频|
大尺度网站污污久久精品|
亚洲大尺码专区影院|
国产亚洲欧美一区二区在线观看|
欧美性高朝久久久久久久|
欧美一区二区三区精品影视|
日韩人妻制服丝袜|
日韩欧美精品国产精品|
亚洲一区二区精品视频|
亚洲欧洲国产精品|
日本激情在线看免费观看视频|
一区二区三区四区五区午夜福利|
久草视频国产在线观看00|
91成人在线视频|
成人久久免费观看麻豆|
日本电影 一区二区三区|
欧美日本激情视频一区二区|
免费不卡一区二区三区视频|
国产探花综合在线一区二区|
最新国产三级在线观看不卡|
男人成人天堂亚洲|
99久精品视频在线观看视频|
国产97精品在线观看|
亚洲悠悠久久综合情|
青青久久精品国产免费看夜夜嗨|
色综合久久婷婷色综合网|
国产区欧美区综合区自拍区视频|
男人成人天堂亚洲|
91成人免费观看在线观看|
91精品国产高清久久久久|
亚洲经典一区二区三区四|
国产精品免费看视频|
亚洲不卡一区午夜免观看|
又黄又湿又色的免费视频|
欧美日韩一区二区久久精品|
国产三级在线观看播放不卡|
亚洲白色白色永久观看|
午夜小视频在线观看|
亚洲日本在线免费观看|
五月综合激情久久婷婷|
999国内精品在线观看|
色哟哟视频在线一区二区三区|
丰满少妇很大胆一区二区|
夜夜嗨av一区二区三区网站|
蜜桃久久久精品免费视频|
欧美视频在线观看你懂得|
日本在线播放亚洲一区|
天堂国产永久综合人亚洲欧美|
日本高清+成人网在线观看|
久久天天躁综合夜夜黑人鲁色|
国产欧美成人一区二区三区|
亚洲国产综合精品|
精品久久综合日本久久网|
日韩av片免费播放|
久久久国产精品一级二级三级|
日本不卡一区免费在线视频|
日韩国产一区二区三区片|
91精品亚洲欧美午夜福利|
欧美国产成人免费观看永久视频
|
欧美成人午夜福利手机在线观看
|
天堂国产永久综合人亚洲欧美|
婷婷色国产5精品视频一区|
嫩草影院麻豆久久视频|
亚洲成年电人电影网站|
国产三级国产精品国产av|
超97视频在线观看国产日韩|
性色av不卡一区二区三区|
国产精品久久久熟女|
婷婷了五月色香综合缴情|
91在线精品老司机免费播放|
欧美一区二区三区在线观看|
久久久婷婷中文字幕|
国产成人自拍视频在线观看|
亚洲精品字幕一区二区三区|
中文字幕第一页av在线|
国产精品91一区二区在线|
欧美国产亚洲二区|
卡一卡二免费在线观看视频|
色黄视频在线观看|
色婷婷7777免费视频|
国内欧美一区二区三区视频
|
午夜国产精品视频|
亚洲国产欧美日韩第一页|
狠狠色婷婷综合激情久久久|
国产精品污双胞胎在线观看|
日本一二三区不卡视频在线观看
|
国产亚洲精品播放|
91伊人色伊人亚洲综合网站|
一级a一级a爰片免费网站|
青青久久精品国产免费看夜夜嗨|
伊人激情精品av一区二区|
亚洲综合精品香蕉久久网|
欧美视频一区二区三区网站|
精品久久久一区二区|
日本高清不卡视频免费观看|
欧美日韩国产三级黄片|
国产一区二区三区视频|
国产图片日韩欧美亚洲|
午夜福利诱惑日韩|
国产精品无产久久久久久|
久久精品网站亚洲另类|
久久久国产精品一二三日韩|
色婷婷综合一区二区在线播放|
成年视频xxxxx在线网站|
一区二区三区国产在线看|
字幕日韩视频一区二区|
亚洲精品第一国产综合野草社区|
视频在线观看 一区二区
|
国产精品日韩久久肉色丝袜交足|
亚洲国产精品人久久电影|
免费va国产精品小视频|
亚洲天堂福利久久|
91在线精品麻豆欧美在线|
日本一高清久一视频二欧美|
日本免费完整版观看|
成人午夜视频在线观看|
在线观看一级免费毛片|
亚洲国产精品人久久电影|
精品一区二区久久久久黄大片
|
午夜精品久久久999麻豆|
日本一区二区三区视频国产|
超碰人人想人人爽人人叫|
国产高清露脸自拍视频在线观看|
国产中文字幕在线观看v片|
国产又黄又爽的刺激视频|
亚洲一区二区三区播放在线|
亚洲男人的天堂网站www|
午夜电影在线免费观看|
激情亚洲国产综合一区二区三区
|
爱福利国产精品视频一区|
欧美日韩国产三级黄片|
亚洲精品成人午夜影院在线观看|
欧美一区二区乱码在线观看|
欧美国产日本韩国一区二区
|
精品丰满少妇A丫久久久久|
国产一区二区福利小视频|
亚洲国产日韩欧美性生活|
丰满少妇大力进入av亚洲|
极品久久久久中文字幕|
在线观看91香蕉国产免费|
日本韩国欧美一级片网站|
欧美高清一区二区三区欧美|
亚洲特色一级视频|
精品美女一区二区三区四区|
欧美精品一区99视频官网一区|
久久中文字幕www|
国产成人精品免费视频网站|
欧美成黄片激情久久久|
青青国产线免观看手机版精品|
欧美美女午夜视频|
麻豆久久99精品福利久久久|
国产日韩久久久精品影院首页|
国产91在线精品免费观看久|
青青草原1769久久免费播放|
亚洲青春草原视频在线观看|
国产破处免费视频|
激情久久丁香婷婷|
亚洲精品色午夜久久久久|
成人精品视频一区二区在线|
最新亚洲欧美日韩|
精品第一国产综合亚洲午夜|
男人的天堂久久久久久久久久|
久久精品视频在线播放|
最新中文字幕av不卡在线播放|
国产亚洲精品久久美女
|
国产人在线成免费视频观看|
欧洲国产精品一区二区三区|
午夜免费电影一区|
国产老熟女精品久久久久影院|
高清中文字幕在线观看网址|
久久99欧美午夜精品久久久|
91美女在线播放|
亚洲欧美清纯丝袜另类|
精品美女一区二区三区四区|
国产中字幕不卡一区|
国产精品污双胞胎在线观看|
亚洲欧美韩国日产综合在线|
欧美美女一区二区三区|
色婷婷狠狠禁18久久yy|
日韩成人免费在线视频|
亚洲人妻av免费在线免费播放|
欧美三级日本在线观看成人|
国产97精品在线观看|
欧美激情第一欧美在线|
亚洲av官网一区二区三区|
免费高清欧美大片在线观看|
亚洲国产一区二区在线|
插美女在线一区二区三区|
久久久久成人黄片|
蜜臀av国内精品久久久夜夜嗨
|
国产精品人成在线播放
|
日韩伦理在线一区二区三区|
视频 国产 日韩 欧美|
日韩一区二区久久久|
精品久久久久久久免费加勒比|
91麻豆精品激情在线观看最新|
伊人国产不卡久久中文字幕|
亚洲一区二区三区四区a v|
国产亚洲精品啪啪视频|
亚洲一级二级三级在线播放|
免费观看美女裸体网站久久|
麻豆久久精品影院|
欧美视频在线观看视频|
欧美在线观看高清不卡|
亚洲精选视频在线观看|
国产 一区二区三区 视频|
亚洲热妇热女久久精品|
欧美成人午夜视频在线观看|
欧美日韩免费在线视频|
国产精品亚洲天堂国产精品|
日本一本天堂免费在线观看|
国产日韩精品黄色av|
黄色一级片黄色一级片|
亚洲免费成人日韩|
亚洲动漫精品一区二区三区|
欧美一级午夜片在线观看|
国产亚洲成人免费在线观看|
国产精品亚洲天堂国产精品|
夜夜嗨久久国产精品综合网|
日本久久久久久久久久人妻视频|
亚洲欧美日韩中文v在线|
国产精品日本一区二区在线播放|
中文字幕 在线播放 第一页|
免费看18级做a爰片久久|
欧美日韩亚洲免费三区|
免费黄色大片视频|
91亚洲中文天堂在线播放|
日韩中文欧美亚洲|
日韩一区三区av在线|
国产日韩在线观看亚洲精品
|
成人黄色免费在线视频|
日韩vs欧美精彩在线视频|
中文字幕日韩久久精品tv|
国产精品国产三级野外国产|
一区二区三区精品免费观看|
日韩中文欧美视频网|
一区二区三区日本福利视频
|
国产综合久久久久久88|
欧美一级片在线免费观看|
亚洲欧美日韩伦理|
日韩亚洲一区二区三区|
偷国产99视频在线观看|
国产日韩亚洲欧洲一区二区三区|
久久久久久久久性生活a级大片|
国产av熟女一区二区三区蜜臀|
亚洲一区二区av动漫在线观看|
久久亚洲综合伊人|
日韩欧美一区在线观看|
av动漫精品一区二区三区|
亚洲一区二区成人|
欧美一区二区三区精品影视|
欧美国产一区二区不卡视频|
国产精品日韩久久肉色丝袜交足|
激情社区一区二区在线免费观看|
日本久久频这里精品|
精品一区二区中文字幕乱|
亚洲精品一区久久狠狠欧美|
日韩精品特级一区二区三区|
91麻豆精品国产自产中文|
欧美视频 国产视频|
亚洲日本午夜福利在线|
日本24小时成人在线视频|
日本一区二区在线视频免费观看|
欧美一区二区在线观看日韩一区|
区欧美日韩综合一区二区|
日本不卡一区免费在线视频|
国产一区二区三区91在线|
日韩视频三区一区|
国产偷自视频区视频一区二区|
欧美一级视频在线免费播放|
国产亚洲国产bv网站在线|
老司机精品免费在线观看|
久久综合一区二区精品视频|
国产成片免费视频app|
日本人体一区二区|
国产福利在线观看一二三|
亚洲欧美视频在线观看一区|
日韩欧美亚洲综合|
日本美女视频一区二区三区四区
|
久久精品欧美一区二区
|
偷拍,清纯,欧美,久久精品|
伊人久久婷婷丁香六月综合基地|
亚洲欧美一区二区久久婷婷|
欧美日韩一区二区三区自拍|
日本高清一区二区三区在线观看|
欧美一级片在线免费观看|
色狠狠成人综合网|
在线免费观看日本视频高清|
色黄视频在线观看|
亚洲国产成人在线观看视频|
麻豆亚洲av熟女国产一区二|
一本久道久综合久久鬼色|
午夜一级黄片在线|
最新网址在线观看一区二区三区|
国产成人久久精品麻豆二区|
久久久久久久一区二区三区毛片|
亚洲国产一区二区在线|
久久国产精品综合|
日韩激情欧美大片一区二区三区|
嫩草影院麻豆久久视频|
亚洲国产一区二区精品专区发布潘金莲
|
在线免费观看成人不卡视频
|
精品欧洲视频一区二区三区|
久久免费手机视频|
少妇spa一区二区三区|
国产亚洲欧美成人91|
欧美黄色大片在线免费观看|
欧美在线观看第一页中文字幕|
欧式午夜理伦三级在线观看|
亚洲视频免费观看|
最近日韩激情中文字幕|
99久久无色码中文字幕福利|
国产在线精品一区二区三区国…|
97色偷拍一区二区三区|
欧美成视频在线观看|
国产成人精品一区二区三区在线观看|
成人精品影院在线视频观看|
日本亚洲欧美一区二区三区在线观看
|
91欧美精品成人综合在线观看|
亚洲精品久久久蜜桃网站|
精品国产制服丝袜高跟
|
久久99精品久久久久久hb|
蜜臀久久久亚洲精品国产|
国产综合精品在线观看91|
亚洲精品中文字幕9999|
国产一级在线播放|
日本女优一区视频在线观看|
免费一区二区三区不卡视频|
在线观看日韩视频免费观看|
青青草原国产免费av|
国产中文久久精品|
国产精品一二三区视频网站|
麻豆久久精品影院|
a看一区二区三区视频在线观看
|
国产高潮呻吟网站在线观看|
久久久噜噜噜久久噜噜熟女|
婷婷久久精品一区0000|
日本一区二区三区电影网站|
亚洲永久乱码免费播放片|
亚洲系列欧美系列国产系列日韩|
中文字幕 在线播放 第一页|
亚洲国产欧美啪啪自拍|
亚洲天堂久久精品|
日韩激情视频欧美激情视频欧美|
99久久精品一区二区|
国产精品久久午夜夜伦|
亚洲日本在线免费观看|
,天天爽夜夜爽夜夜爽精品视频|
日本成人影在线观看国产精品|
精品国产一区二区三区av明星|
精品国产大片久久久久久久久|
亚洲一区二区三区 视频在线|
国产日产欧美最新|
日本理论片手机在线观看影片|
在线免费视频 中文字幕|
精品国产91在线看|
国产91精品欧洲在线观看|
国产成人亚洲综合av|
欧美视频一区二区三区在线
|
亚洲综合色网在线观看|
日韩欧美中文字幕免费在线观看|
精品91精品91精品国产片|
亚洲av成人一区国产精品|
欧美亚洲日本国产一区三欧美|
日韩中文欧美亚洲|
国产原创av在线 免费播放成人一区二区三区四区
|
国产大片欧美精品|
国产高清在线精品一区导航|
欧美一区二区三区高清不卡tv|
久久欧精品欧美精品日韩精|
在线观看一区二区三区不卡|
免费自拍视频在线 国产综合|
亚洲国产成人综合网站|
丝袜国产在线观看|
日韩亚洲欧美中文在线网|
国产小视频在线免费|
久久影视中文字幕一区|
亚洲一区二区精品视频|
久久精品亚洲毛片美女极品视频|
最新中文字幕av不卡在线播放|
亚洲人成网站在线在线观看|
最近最新中文字幕一区二区|
亚洲www视频免费在线观看|
日日拍夜夜嗷嗷叫人人妻人人爽|
欧美日产国产在线视频|
欧美日韩激情一区第二页|
精品丰满少妇A丫久久久久|
久久久不卡一区二区三区|
懂色av一区二区久久|
中文字幕不卡一区二区精品|
国产亚洲自拍成人|
不卡视频在线观看国产|
久久久av一区二区三区|
男人午夜的天堂视频在线观看|
婷婷丁香综合亚洲激情|
欧美成人一区视频|
亚洲激情av在线免费观看|
99精品国产成人观看免费不卡
|
麻豆成人永久久久|
国产精品性色av一区二区|
日本爱爱一区二区|
看免费黄色一级视频|
日韩高清在线久久|
日韩在线欧美成人|
五月婷婷综合在线视频网|
在线观看国产一区二区视频|
亚洲乱码av中文一区二区|
好吊妞国产欧美日韩在线观看|
久久综合九色综合97手机观看
|
久久精品欧美一区二区三区麻豆|
欧美91精品久久久久影视网|
国产中文字幕高清免费|
欧美国产日韩电影|
亚洲日本韩国一区二区在线|
中文字幕亚洲综合久久男男|
99久久综合国产精品二区国产|
国产 精品 欧美 综合 在线|
一区二区三区四区五区午夜福利|
中文字幕在线观看91色|
欧美 日韩 亚洲 区 在线看|
国产精品电影一区|
欧美日韩一区二区中文成人|
欧美黄色日韩成人|
婷婷久久综合九色国产成人|
日韩免费毛片电影|
免费观看美女福利视频一区二区
|
成人精品一区二区三区中文字幕|
日本午夜在线观看网站免费|
色婷婷色丁香久久婷婷|
av中文字幕一区二区在线观看
|
日韩小视频在线播放|